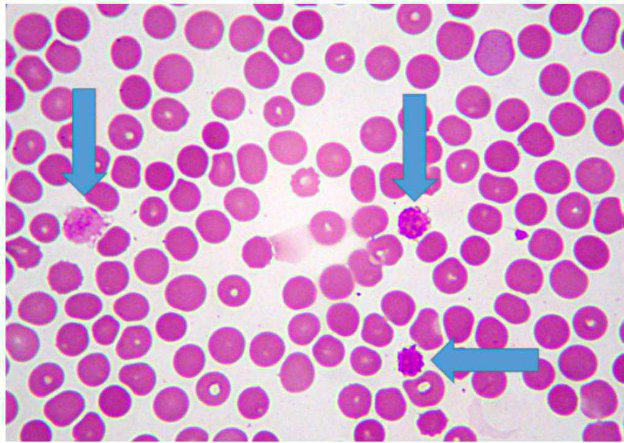
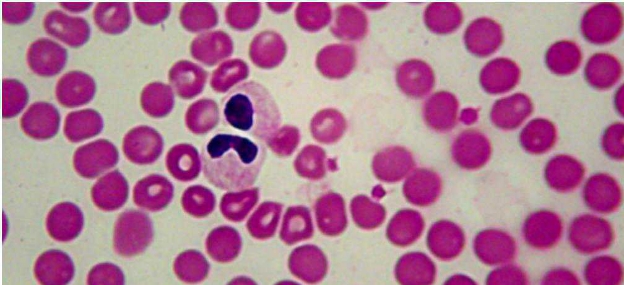
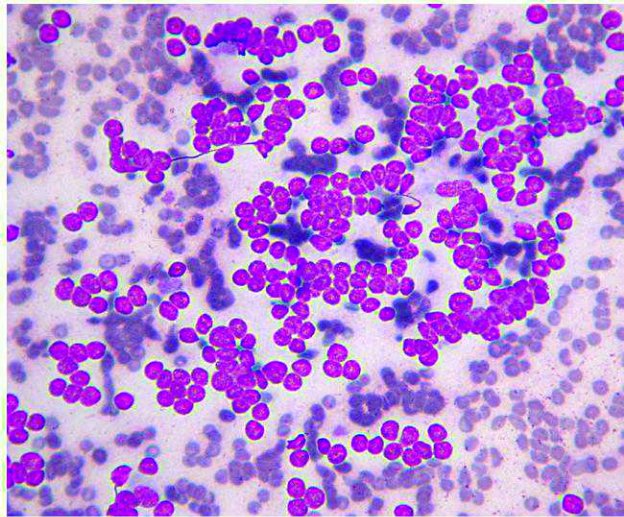
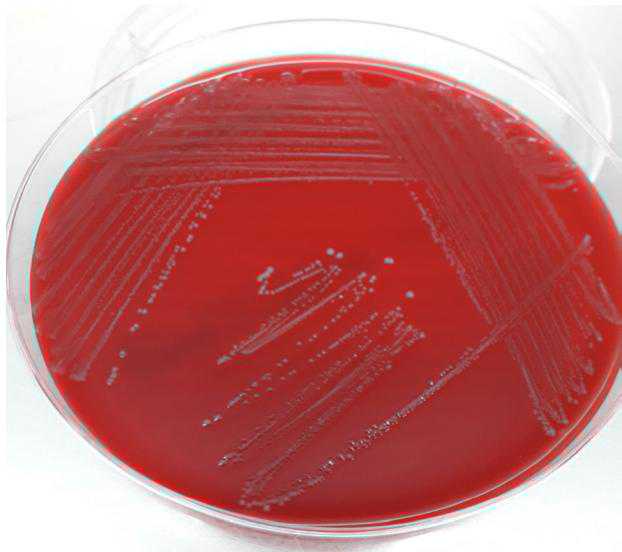

Laboratorio La Vallonea
Il lavoratorioi dei clinici per i clinici


A cura di
Tutti gli Autori degli articoli sono
Esperti MYLAV

Il nostro servizio di consulenza per i casi clinici più complessi.
Articoli di aggiornamento scientifico redatti dai nostri Consulenti.
Prof.ssa Francesca Abramo
Dr. Francesco Albanese
Prof. Luca Aresu
Dr.ssa Barbara Banco
Dr. Massimo Baroni
Dr.ssa Silvia Benali
Dr. Walter Bertazzolo
Prof. Giuliano Bettini
Dr. Ugo Bonfanti
Dr. Enrico Bottero
Prof. Paolo Buracco
Dr.ssa Maria Chiara Catalani
Dr. Francesco Carrani
Dr.ssa Marta Claretti
Dr. Davide De Lorenzi
Prof. Nicola Decaro
Dr. Francesco Dondi
Dr. Giuseppe Febbraio
Prof. Federico Fracassi
Prof. Gualtiero Gandini
Dr.ssa Floriana Gernone
Dr.ssa Magda Gerou Ferriani
Dr.ssa Selina lussich
Dr. Federico Leone
Dr.ssa Laura Marconato
Dr. Michele Marino
Dr.ssa Marta Medardo
Dr.ssa Lucia Minoli
Dr. Domenico Multari
Dr.ssa Luisa Vera Muscatello
Dr. Fabio Necci
Dr.ssa Margherita Orlandi
Dr.ssa Teresa Bruna Pagano
Prof. Saverio Paltrinieri
Dr. Fabio Procoli
Dr. Luca Pazzini
Dr. Gustavo Picci
Dr.ssa Maria Carmela Pisu
Dr.ssa Federica Rossi
Dr.ssa Giliola Spattini
Dr. Giovanni Tortorella
Dr. Luigi Venco
Dr. Luca Vezzoni

Cari Colleghi,
vi presentiamo il Book MYLAV 2021 -
Volume della Collana Editoriale “Le Pillore di scienza” che come agli anni raccoglie i più interessanti “Post di aggiornamento scientifico” pubblicati sul loro Blog MYLAV nell’anno precedente.
Il Blog MYLAV (www.mylavblog.net) è lo strumento che da voce ai nostri Esperti Mylav e ci permette di pubblicare settimanalmente articoli di aggiornamento scientifico, consigli pratici e riassunti di articoli scientifici di recente pubblica-zione.
Tutti gli argomenti vengono trattati e discussi in maniera pratica e simplice come più avvenire in una discussione fra colleghi maenza rinunciareagli aspetti tecnici e scientifici.
La Collana Editoriale “Pilole di scienza” nelle versioni eBook, Audiobook e Podcast fornisce differenti modalità per aggiornarti dove vuoi e quando vuoi.
Il Blog MYLAV viene curato da Walter Bertazzolo e Ugo Bonfanti.
Tutti gli Autori dei Post sono Esperti MYLAV e Collaboratori
Dir. Resp. Isidoro Grillo
Ogni volta che ci troviamo di fronte a risultati di lavoratorio un po’ “strani”, prima di iniziare ad avventurari in inutili elucubrazioni diagnostiche, è importante sempre essere certi che quella anomalia non sia semplicamente una caratteristica fisiologica normale per那一zza.
Ciò accade con una certa Frequenza in particolare in ematologia, biochimica clinica ed endocrinologia: cercHERò di farvi alcuni esempi più o meno Frequenti: Eritrociti troppo piccoli o troppo grandi.
RBC
: 8.35 6,2 8.1
HGB (g/dL): 15.10 15,7 19,9
Cellular HGB (g/dL): 15.40 15,3 19,2
Hct (%): 49.10 46,9 60,8
MCV(fL): 58.80 68,5 79,3
MCH (pg): 18.10 22,3 26,1
MCHC (g/dL): 30.80 31,6 35,1
CHCM (g/dL): 31.40 29,8 34,4
CH (pg): 18.40 21,1 25,4
CHDW (pg): 2.29 2.7 3,3
RDW(%):12.90 11,7 13,6
Figura 1 - Imagine tratta da un emogramma di akita inu, con un aumento degli RBC ma con concentrazione di emoglobina ed ematocrito praticamente nella norma. Trattandosi di RBC più piccoli (MCV 58) è di consegenza ovvio avee un contento di emoglobina eritrocitaria ridotta (MCH e CH), a fronte di una concentrazione emoglobinica intra-eritrocitaria praticamente normale (CHCM).
In alcune razze è comune una microcitosi fisiologica.
Per esempio si osserva tipicamente in alcune razze giapponesi, come gli akita inu. In questi soggetti sarenormale quando osservare un numero elevato di RBC a fronte di una concentrazione di emoglobina e di ematocrito assolutamente normali.
Non si tratta quando di una reale eritrocitosi e non bisognerà pertanto iniziare un iter diagnostico per le varie cause di policitemia.
In autre razze si cui ovo viceversa osservare una macrocitosi fisiologica.
É il caso ad esempio dei barboncini. Nell’immagine seguente, trattada un emogramma di cane sano di questa razza, è evidente una riduzione
ne del numero di RBC, che pero es-. sendo molto voluminosi, conducono ad una concentrazione di emoglobina ed ematocrito normali. Per cui non possiamo parlare di vera anemia, ma di una condizione normalissima per questo paziente.
Parlando sempre di ematologia, tutti ormai conoscono la macro-trombocitosi dei Cavalier King Charles Spaniel, che è spessissimo assocata a forme asintomatiche di piastrinopenia.
Figura 2 - Tratta da un emogramma di un barboncino normale. In quello caso la situazione è esattamente opposta rispetto al caso precedente, per cui MCH e CH risulteranno oviamente aumento ma con un CHCM alla normale.
RBC (x10^6/μL): | 5.04 | 6,2 | 8.1 |
HGB (g/dL): | 16.80 | 15,7 | 19,9 |
Cellular HGB (g/dL): | 16.50 | 15,3 | 19,2 |
Hct (%) | 55.50 | 46,9 | 60,8 |
MCV (fL): | 110.10 | 68,5 | 79,3 |
MCH (pg): | 33.30 | 22,3 | 26,1 |
MCHC (g/dL): | 30.20 | 31,6 | 35,1 |
CHCM (g/dL): | 29.80 | 29,8 | 34,4 |
CH (pg): | 32.80 | 21,1 | 25,4 |
CHDW (pg): | 4.54 | 2.7 | 3,3 |
RDW (%) | 14.00 | 11,7 | 13,6 |
Questi cani hanno poche piastrine ma
molto più voluminous, il che conduce ad una piastrinocrito pressché normale. Dato che per la funzionalità piastrinica conta di più la massa globale circolante del numero di piastrine, è compresibile che questi cani non abbiano problemi emostatici.
Questa alterazione familiare geneticamente trasmissibile, è stata riscontrata anche in altre razze (es. Norfolk terriers, Cairn terriers)anche se con alcune piccole differenze di mutazione coinvolta e di modalità di trasmissione. Negli Akita Inu, una manna per gli ematologi veterinari a quanto pare, è frequente imbattersi in cani sani con trombocitopenie persistenti,anche di importante entità, per le quali tuttavia non esistono più spiegazioni eziopatogenetiche e geneticale accertate.
Figura 3 – Macrotrombocitosi in un Norfolk terrier: alcune macropiastrine sono indicate dalle freccce ed hanno un volume stimabile apparentemente simile a quello di un eritrocita.
Abbiamo più discusso in passato sulle peculiarità ematologiche dei Greyhounds e levrieri simili, e non vi tornerò in questo blog (per chi fosse interessato più consul- tare l’argumento a quello link: https://www.mylavblog.net/generica/165-165.html)
In relazione ai leucociti, possiamo portare l’esempio degli Australian sheep dog, che con una certa Frequenza molto l’anomalia di Pelger-Heut, nella quale i polimorfo-nucleati neutrofili ed eosinofili sono inceve quasi esclusivamente bandati. Cio non deve indurci a pensare in questi casi ad una sepsi!
Figura 4 - Esempio di neutrofili con anomalia di Pelger-Heut in un pastore australiano.
Anche in biochimica clinica è possible osservare apparenti anomalia a carico di alcuni analiti, che perché sono fisiologici in quella specifica razza.
L’esempio più eclatante è quello della creatinina dei gatti Birmani, che è spesso superiore a 2 mg/dL pur in assenza di patologia renale progressiva.
E che dire dei maltesi, che hanno fisologiçamente gli acidi biliari sierici molto più alto?
E altri esempisi si possono portare in endocrinologia: nei levrieri e nel dogue de Bordeaux, i profili tiroidei devono essere interpretati con cautela per evitare diagnosi errate, in quanto quosti cani hanno fisologiamente valori di T4 più bassi degli altri cani adulti sani.
Quindi, agli qualvolta vi ritrovate dei valori di lavoratorio un po’ strani in una cane o gatto di razza, provate a googolarli perché è molto probabile che qualcuno prima di voi li abbia notati e li abbiaanche più descritti.
Walter Bertazzolo, Direttore Scientifico di MYLAV
Qualunque clinico vorrebbe avee dei “numeri” di laboratorioio assolutamente affidabili, che alla cunc dubbio possano essere utilizzati per definire determinate situazioni fisiologiche o patologiche.

Purtroppo,anche il più preparato degli internisti, spesso dimentica un particolare fondamentale: ovvero che questi “numeri” sono il risultato di misure analitiche e come tali soffrono di potenziali fonti di variabilità.
Prendendo spunto da alcuni studi recentamente pubblicati sulla valutazione della concentrazione dell’urina del cane e del gatto (quello che molti di moi conoscono meglio come Peso Specifico urinario, PS), cercHERò di illuminarvi su alcuni aspetti della medicina di lavoratorioi negletti alla maggior parte dei clinici.
Gli esseri viventi appartenenti ad una determinata specie non sono oviamente tutti uguali. La diversità biologica è il motore fondamentale dell’evoluzione.
Ogni veterinario è ben conscio delle differenze estreme che esistono ad esempio nei fenotipi delle diverse razze della specie canina. Quindi, come abbiamo recentamente commentato sul nostro blog, le differenze di razza sono essere molto importanti per interpretare un determinato dato di lavoratorio. Lo stesso diciasi per altre variabili (sesso, età, stato di nutrizione, ecc.). Questa variabilità viene definita inter-individuale ed è ben comprensibile.
Più subdola è,invece la variabilità intra-individuale:le nostre “misure biologiche” cambiano continuamente, pensiamo ad esempio alla glicemia, alla pressione arteriosa, al peso corporeo e così via.
Queste variazioni possono essere circadiane oppure random e dipendere da tan-tissimi fattori (es. la dieta, l’esercizio fisico, l’assunzione di acqua, ecc.). Facciamo quando I’esempio del PS urinario, che usiamo giornalmente per stabilire la capacité di concentrazione renale dei nostri animali.
A tale proposito, siamo abituati ad utilizzare dei cut-off molto netti per prendere delle decisioni cliniche: un cane disidratato ed dovrebbe avere delle urine con un PS
per poter dire che i loro reni concentrino correttamente e quando non ci saa un sottostante problema renale. Ma quando può cancellare il PS urinario in un singolo individuo durante la giornata? Uno studio recente ha dimostrato che la variabilità del PS urinario nei cani sani su urine raccolte alla mattina per 6 giorni diversi nell’arco di 2 settimane, è in media di circa 0.015 (Rudinsky et al, JVIM 2019). Molti di questi cani avevano oscillazioni superiori a 0.020 (ad esempio da 1.015 a 1.040). Quindi, quando dobbiamo prendere decisioni diagnostiche o cliniche sulla base di una singola misura, dobbiamo sempre domandarci: ma può essere dato essere anomalo per effetto di una variabilità biologica intra-individuale? Il dato che ho osservato può essere giustificato da una condizione patologica oppure essere più banalmente il risultato di una variabilità giornaliera di quello specifico paziente?
Quando misuriamo un analita e produciamo il nostro fatidico “Numero” di lavoratore, un’altra casa che i clinici sottostimano, è l’effetto della variabilità analitica. Tutti vorremmo ad esempio, che quando misuriamo la creatinina non ci sa alcuna differenza tra uno strumento e l’altro,osi da poter confrontare liberamente i risultati ottenutianche con diversi strumenti o lavoratori di riferimento. Purtroppo但这a è una visione utopistica e un po’ limitata del problema.
Ritornando all’esempio del PS urinario, gli stessi autori sobre menzionati, hanno valutato in un’alto studio l’effetto della variabilità analitica dovuta all’utilizzo di
rifrattometri diversi per misurare la concentrazione urinaria (Rudinsky et al Vet Clin Pathol 2019).
Ebbene, da questo studio è risultata in generale una Buona correlazione ed agre-ement tra 3 diversi refrattometri, nelle un’alto migliorava valori meno accettabili.
La differenza di PS urinario utilizzando diversi strumenti perfettamente calibrati, cui superare infatti lo 0.005, che in prossimità di un cut-off diagnostico potrebbe farci cancellare la nostra interpretazione: pensiamo se un’urina che ha un PS reale di 1.040, venisse invece misurato come 1.032; tramremmo le stesse conclusioni cliniche? Oppure se invece che essere 1.010 fosse 1.005?
Produitori di strumenti e lavoratori di analisi investono molto tempo e denaro per ridurre al minimo le diverse fonti di variabilità analitica, e quello post non vuole di essere essere una dissentazione sull’argumento, in quanto richiederebbe un livello di approfondimento che probabilitmente non interessa nessun clinico. Questo post vuole perché essere di provocazione, per farvi apree un po’ di più gli occhi sull’interpretazione dei risultati che agli giorno vengono prodotti in un lavoratorio di analisi. Quando li valutiamo e facciamo dei confronti tra numero ottenuti in diversi momenti e/o con strumenti differenti, dobbiamo sempre tener conta che le differenze di risultati pottrebbero essere riconducibili ad una sommatoria di variabilità: biologica + analitica.
Nello studio di Rudinsky et al (2019) è stato valutato inoltre un altro dato interessante, già studiato ampiamente in altri lavori passati: overo la correlazione e l’agreement tra la misura del PS urinario e l’osmolarità urinaria. Che differenze ci sono? Quale è più utile ed accurato nella stima della capacité di concentrazione urinaria? Ve ne parlò nella prossima puntata perché si tratta di un argomento specifico interessante.
Rudinsky et al. Variability among four refractometers for the measurement of urine specific gravity and comparison with urine osmolality in dogs. Vet Clin Pathol 2019. Rudinsky et al. Variability of first morning urine specific gravity in 103 healthy dogs. J Vet Intern Med 2019.
Walter Bertazzolo, Direttore Scientifico di MYLAV
La valutazione della capacité di concentrare le urine, è un aspetto fondamente in medicina interna, in quanto ci permette di capire come sta reagendo il nostro apparato escretore alle differenti condizioni fisiologiche.
Sapere se i reni sono in grado di concentrare o diluire le urine nelle varie condizioni cliniche, è pertanto uno step esseniale per l’internista nel percorso diagnostico di molte patologie.
La concentrazione urinaria viene solitamente determinata misurando il peso specifico (PS) mediante semplici strumenti di misura a basso costo (rifrattometri). Tuttavia, il metod di riferimento per misurare la concentrazione delle urine (o di qualsi soluzione in generale) è l’osmotetria.

Figura 1 - Osmometro utilizzato in ambito chimico clinico.
Cerchiamo di spiegare quali sono le differenze tra le due misurazioni. Il PS misurato con i rifrattometri è in realtà una stima della concentrazione urinaria: lo strumento trasforma l’indice di rifrazione (IR) di una soluzione (le urine in quello caso) in un PS stimato.
Molti rifrattometri riportano infatti entrambé le scale di misura (IR e PS). Questa semplice technologia viene sfruttata in diversi ambiti, per esempio in viticoltura si usano i rifrattometri per valutare il contento zuccherino dell’uva prima della vendemmia.
Gli osmometri sono strumenti analitici che permettono di misurare con precisione la concentrazione di una soluzione: essi ne misurano infatti l’osmolarità o l’osmo
lalità. Queste non sono proprio uguali, in quanto indicano rispettovamente la concentrazione in Osmoli di soluto su libro di soluzione (Osmolarità) oppure Osmoli di soluti su kg di soluzione (Osmolalità).
Normalmente in medicina si considera la seconda misura, quindi dovremmo sempre parlare di Osmolalità.
Premesso che ovviamente la misura diretta dell’Osmolalità è più accurata della misurazione del PS, quali sono le reali differenze tra le due? Nella stragrande maggioreanza dei casi esiste un’eccellente correndazione tra PS e Osmolalità, dimostrata in numerousi studi nelle’uomo e negli animali. A titolo espicativo, vi mostro alcuni esempi di confronto tra le due misure:
PS 1.001 corrisponde a circa ![]()
PS 1.005 corrisponde a circa ![]()
PS 1.010 corrisponde a circa ![]()
PS 1.015 corrisponde a circa ![]()
PS 1.020 corrisponde a circa ![]()
PS 1.040 corrisponde a circa ![]()
PS 1.060 corrisponde a circa ![]()
Un’urina con concentrazione di 1000 mOsm/Kg per esempio, sare è due volte più concentrata di una con 500 mOsm/Kg. Una urina con PS di 1.030 sare “approssimativamente” due volte più concentrata di una con PS di 1.015, quello perché – come più detto – la rifrattometria non misura direttamente la concentrazione, ma ne determina una stima. Nella pratica clinica l’uso del rifrattometro è ormai estremamente diffuso,anche perché esiste una notevole differenza diosti tra un rifrattometro ed un osmometro, e i risultati tra le due misure sono quasi sempre correlati in maniera sufficiente per garantire una interpretazione clinica corretta.
Ci sono perché situazioni in cui la misurazione dell’osmolalità urinaria è sicuramente più “sicura” per la valutazione della concentrazione urinaria, di quella del PS. Per capirlo, devo fare una premessa. L’osmolalità di una soluzione è una propietà colloidale, ovvero significata che il suo valore dipende esclusivamente dal numero di ioni o molecole inessa contente, non alla loro dimensione. Immaginiamo di
avere tre soluzioni acquose differenti: nella prima abbiamo disciolto 10 piccoli ioni (per esempio di sodio e cloro), nella seconda dieci molecole di glucosio e nella terza 10 molecole di albumina. Le tre soluzioni avranno la stessa osmolalità. Tuttavia siccome i tre diversi soluti hanno pesi completamente diversi (l’albumina è molto più grande e pesa molto di più del glucosio, che a sua volta pesa molto di più dei piccoli ioni), il PS delle tre soluzioni sare è differente.
Ci sono studi dai risultati un po’ contrastanti, che hanno valutato l’effetto che i vari soluti “pesanti” possono avere sul PS urinario. In molti casi il PS rimane una stima sufficientemente accurata per una valutazione clinica, ma se abbiamo a che fare con urine con un elevato contento di soluti “patologici” come glucosio, proteine, ketoni, farmaci, mezzi di contrasto radiografici, emoglobina, bilirubina, ecc., la valutazione della loro concentrazione mediante la stima del PS potrebbe essere inficiata, e quindi sarebbe meglio, per valutare la effettiva capacité di concentrare o diluire le urine da parte del rene,fare riferimento alla osmolalità misurata.
Walter Bertazzolo, Direttore Scientifico di MYLAV
Ugo Bonfanti, Direttore Sanitario di MYLAV
Le colorazioni istochimiche speciali e l’esame immunoistochimico sono delle tec- niche diagnostiche ancillari all’esame istopatologico, che possono essere richieste/suggeste per confermare la diagnosi o fornire informazioni aggiuntive rispetto a quanto osservabile con la sola valutazione istopatologica (con colorazione di routine Ematossilina ed Eosina).
Nella maggior parte dei casi si tratta di esami eseguibili sul campione più inviato in formalina e solo una piccola percentuale di colorazioni va eseguita su campione di tessuto non fissato in formalina e congelato. Anche se si differenziano significativamente per la metodologia, sempliciticamente siouldo aftermare che entrambé le tecniche hanno l’obiettivo di identificare/evidenziare strutture/componenti intra o extracellulari nellesezioni di tessuto.
Con tali metodiche, la sezione di tessuto viene sottoposta a reazioni chimiche attraverso le quali le strutture tissutali assumono colorazioni diverse a seconda di casa si vuole evidenziar.
Possono essere utilizzato per:
È importante sottolineare che per quanto riguarda la ricerca/evidenziazione di agenti eziologici, la colorazione istochimica NON si sostituisce all’esame colturale
o alla biologia molecolare e generalmente non permette di classificare la specie dell’eventuale patogeno.
La colorazione istochimica semplicamente permetterà di “vedere meglio” l’agente eziologico se presente. Talvolta la morfologia dell’agente sareva sufficiente a classificarlo precisamente ma talvolta si potrasyolo confirmare la presenza di un agente e classificarlo come batterico, fungino, ecc. Infine, alcune di queste colorazioni possono essere applicate con la stessa utilitàanche su preparatici citologici (colorazioni citochimiche).

Figura 1 - Colorazione istochimica PAS per evidenziare ife fungine (ben visibili in rosa intenso/fucsa), in un caso di aspergillo si nasale del cane.
L’esame immunoistochimico, come indica il nome stesso, prevede l’utilizzo di anticorpi attraverso i quali sare possibile individuare specifiche molecole nella sezione di tessuto.
L’esame immunoistochimico più essere seeguito per via diretta o indiretta,anche se attualmente la maggior parte dei kit e coloratori automatici,utilizzano una metodologia indiretta. La metodica indiretta si avvale di un anticorpo definito “primario” che legherà un determinato antigene che si vuole identificare nella sezione di tessuto. L’avvenuto legame tra antigene e anticorpo primario verrà evidenziatoattraverso una reazione enzimatica con deposizione di un colorante (generalmente marrone) nel situ di avvenuta reazione, mediante l’uso di un anticorpo secondario in grado di innescare la reazione che conducce alla formazione di colore.
Nella diagnostica di routine l’esame immunoistochimico viene principamente utilizzato per una migliorare caratterizzazione delle neoplasie la cui istogenesi non può essere totalmente definita con la sola valutazione istopatologica.
Per tale scopo vengono utilizzati anticorpi che legano componenti cellulari intracitoplasmatici (es. citocheratine, vimentina), della membrana cellulare (es. CD3, CD20) o nucleari (es. MUM1) che sono specifiche e presenti in una o più popolazioni cellulari. L’utilizzo di uno o, più spesso anticorpi multipli, permette spesso di identificare il fenotipo e l’istogenesi delle cellule neoplastiche.
È essenziale ricordare che tale tecnica non permette differenziate tra processi neoplastico e reattivo in popolazione cellulari ben differenziate.
Al contrario, in neoplasie anaplastiche o scarsamente differenziate, l’esame immunoistochimico cui essere non definitivo, in quanto il processo di “sdifferenzazione” cui implicare la “perdita” dell’espressione delle molecole fenotipiche specifiche che le caratterizzano, e pertanto risultare non definitivement classificabili. Si

Figura 2 - Esempio di colorazione immuno-istochemica con CD20 per la confirma e la tipizzazione di un linfoma B-cell.
segnalainoltré che il numero di anticorpi disponibili e di cui è presente una sufficiente letteratura di riferimento in medicina veterinaria, è limitato, e talvolta non è possibile proporre l’utilizzo di marcatori specifici per l’une o l’altra istogenesi.
Altre indicazioni per eseguire/suggerire l’esame immunoistochimico sono:
Per la ricerca di agenti eziologici è necessario sottolineare alcune differenze rispetto alle colorazioni istochimiche speciali discussse precedentemente. Come gli detto, nell’esame immunoistochimico si testano anticorpi specifici e se l’esito è positivo si può confirmare la presenza di un-agente specifico che si è ricercato. L’esame immunoistochimica per malattie infettive in medicina veterinaria trova un
particolare utilizzato per malattie virali (es. Coronavirus nelle lesions da FIP del gatto) e per la ricerca di amastigoti di Leishmania.
È importante segnalare come alcuni fatti possano incidere sull’ottimale riuscita dell’esame immunoistochimico e quindi renderse l’esame non praticabile o definitivo: alcuni trattamenti (es. corticosteroidi nel linfoma), sono alterare le caratteristiche fenotipiche delle cellule che sono risultare negative. Un’inadeguata (scarsa oecessiva) fissazione del campione, con presenza di autolisi e necrosi, sono inficiare l’ottimale riuscita dell’esame. Se il campione è molto esiguo potrebbe essere sconsigliabile eseguire l’esame immunoistochimico (cosi come altri approfondimenti).
Va infine sottolineato che alcune solo alcune colorazioni immuno-istochimiche possono essereanche applicate ai campioni citologici (es. Immuno-citochimica per CD3 e CD20, per la tipizzazione di un linfoma), ma è importante rivolgersi al lavoratorio per averere informazioni sulla fattibilità dell’esame. Inoltre, la qualità e la fattibilità della procedura sui campioni citologici, è fortemente influenzata alla qualità e alla cellularità degli stessi.

Figura 3 - Esempio di colorazione immuno-citochimica su un preparato citologico di linfoma.
Linfoma: in caso di sospetto linfoma, o per perfezionarne la classificazione, si ricorre ai marcatori CD3 e CD20 per identificare cellule ad immunofenotipo T o B rispettovamente.
Nota bene: esistono casi di linfoma negativi per entrambi gli anticorpi. Talvolta l’esame immunoistochimico non è sufficiente a definire la diagnosi di linfoma e potrebbe essere suggerito l’esame di clonalità linfoide. Va sottolineato che quest’ultimo non va usato come definizione del fenotipo, ma per discriminare tra una neoplasia linfoide o processo reattivo/inflammatorio non neoplastico.
Mastocitoma: le colorazioni istorichimiche Blu di Toluidina e GIEMSA spesso evidenziano i granuli dei mastociti (normali e neoplastici), che vengono definite metacromatici. Queste colorazioni possono essere suggerite per confermare il sospetto di mastocitoma e migliorare la sensibilità nel ricercare e quantificare mastociti in un linfonodo. Quest’ultima evenienza permette di classificare l’eventuale coinvolgimento linfonodale secondo la classificazione di Weishaar (J. Comp.Path. 2014, Vol. 151, 329-338).
Nota bene: le negatività per Blu di Toluidina e GIEMSA non esclude la diagnosi di mastocitoma, per esempio in quelli poco differenziati.
L’anticorpo CD117/cKITieneutilizzato inimmunoistochimica come marker per l’origine mastocitica e I’eventuale pattern di positivita individuato, in caso di mastocitoma cutaneo o sottocutaneo, fornisce informazioni prognostiche.
Similmente, Kl67 è un indice di proliferazione e viene suggerito a fini prognostici.
Melanoma: la colorazione istochimica Fontana-Masson evidenzia la melanina e viene suggerita in neoplasie di sospetta origine melanocitaria poco/non pigmentate per ottenere conferma della diagnosi.
Sono molleplici,invece i marker immunoistochimici che nel tempo si sono utilizzati per indicare l’origine melanocitica di neoplasie non pigmentate. Attualmente i piùutilizzati sono PNL2 e Melan A.Nel nostro laboratorioio, il Melan A è incluso nell’anticorpo “Melanoma Triple Cocktail” che includeanche altri due anticorpi meno noti. Secondo la letteratura, I’utilizzo combinato di PNL2 e Melan A, permette diavere una sensibilità superiore al
nell’identificazione dei melanomi.
Nota bene: una piccola percentuale di melanomi non pigmentati (in genere a cellule fusate) è negativo per entrambé le colorazioni e pertanto non è diagnosticabile a seguito dell’esame immunoistochimico.
KI67 è un indice di proliferazione e viene suggerito a fini prognostici.
CSPG4 viene proposto perché la sua valutazione è utile in caso di terapia elettrovaccinale sperimentale (Piras et al. Vet Comp Oncol. 2017 Sep;15(3):996-1013).
Neoplasie epitheliali: le molecule che si utilizzato per l’identificazione immuno-stochimica dell’istogenesi epithelia sono le citocheratine. Esistono numerous citocheratine (filamenti intracellulari), alcune presenti in molte cellule di origine epiteliale (citocheratine AE1/AE3 o pancitocheratina), nelle altre sono specifiche per una o poche linee epitheliali (es. Citocheratina 7: alcuni epiteli ghiandolari ed epitelio uroteliale; Citocheratina 14: epitelio basale).

Figura 4 - Esempio di applicazione di una colorazione per citocheratine per identificare definitamente cellule metastatiche poco differenziate, in una lesione cutanea di cane.
Neoplasie endocrine/neuroendocrine: Sinaptofisina e Chromogranina A
Neoplasie tiroidee: a seconda dell’origine cellulare sono variabilmente positive per Calcitonina, TTF-1 (thyroid transcription factor-1); Tireoglobulina.
Plasmocitoma: MUM1
Origine istiocitica: CD18 (è un marker “panleucocitario” quando saranno positivi anni che altri leucociti quali i linfociti), IBA1 (specifico per istiociti/macrofagi).
Origine muscolare: actina muscolo liscio (SMA), desmina (muscolo striato), e molti altri che identificano varie molecole delle cellule muscolari.
Origine endoteliae: fattore VIII, CD31
Origine miofibroblastica: calponina
Le tecniche immunoistochimica ed istochimica sono esami in cui il patologo INTERPRETA il risultato e formula delle conclusioni a seguito di un quadro complessivo, istopatologico e, possibilmente, clinico-anamnestico riferito dal veterinario curante.
L’esame immunoistochimico/istochimico di per sé non distinguue tra cellula inflammatoria/reattiva/iperplastica e neoplastica, ma è il patologo che interpreta il risultato e talvolta l’esame perché non essere definitivo.
Gli esempi forniti servono per illustrare situazioni “comuni” e frequenti che indica- no perché alcune istochimiche ed immunoistochimiche siano suggerite dal patolo nel contesto di un referto istopatologico.
Gli esempi forniti NON rappresentano un algoitmo diagnostico a cui affidarsi richiedendo esami nella consultarsi con il patologo referente che avrare valutato il caso nel suo complesso e alla luce delle possibili diagnosi differenziali.
Gli esempi indicati NON rappresentano un elenco ESAustivo degli anticorpi disponibili in medicina veterinaria e nelle specifico dal nostro lavoratorioio.
Silvia Benali, Patologodel team MYLAV
Ogni giorno processiamo centinaia di profili biochimici, e agli giorni ce n’é qualcuno che mystra queste gravi alterazioni biochimiche:
Questo induce molti clinici a pensare: “cosa avrà di casi grave questo animale” oppure “il lavoratorio ha sicuramente contaminato il mio campione”… ecc.
Ebbene la risposta è molto semplice in realtà le gravi alterazioni elettrolitiche sono al 100% la conseguenza di contaminazione con EDTA, anticoagulante d’elezione per l’esame emocromocitometrico, che è un’evenienza, come più sottolineato, davvero molto frequente.
Il problema si realizza appena dopo che avete prelevato il sangue in siringa da un vosto paziente. Quando si sposta il sangue alla siringa alla provetta da emocromo, il cono della siringa stessa cui venire a contatto con tracce di anticoagulante toccando la provetta più o meno inavvertamente nella sua parte interna.
Quando successivamente trasferite il sangue residuo nella provetta da siero o con litio eparina, viene trascinataanche una piccolissima quantità di EDTA alla prima.
Quantità minime di但这a sostanza hanno il potere di chelare molto efficacamente il calcio, il ferro ed il magnesio. Inoltre, contenendo molto potassio (trattandosi di K₃EDTA), quello elettrolita verrà invece addizionato al campione.
Vi mostriamo un video di come questo può accadere: non è poi così improbabile, no….?
Walter Bertazzolo, Direttore Scientifico di MYLAV
Ugo Bonfanti, Direttore Sanitario di MYLAV
Che effetto più avere il prelievo di urine a casa o in clinica sulla misurazione della proteinuria e dell’escrezione del cortisolo urinario? Lo ha valutato un recente studio pubblicato sul Journal of Veterinary Internal Medicine.
Studi nell’uomo e negli animali hanno dimostrato che le condizioni stressanti sono aumento la produzione di cortisolo e quandoanche la sua escrezione urinaria; come possibile consequences,anche la proteinuria cui risultare augmentata in queste situazioni.
Il motivo per cui lo stress possa indurre proteinuria è probabilitmente legato ad una transitoria ipertensione glomerulare ed augmentata permeabilità capillare.
L’ipercortisolismo causa comunmente proteinuria ante nel cane (ad esempio nei cani con il morbo di Cushing è un rilievo extremamente comune).

In un recente articolo pubblicato sul Journal of Veterinary Internal Medicine (Citron et al 2020: “Urine cortisol-creatinine and protein-creatinine ratios in urine samples from healthy dogs collected at home and in hospital”), è stato valutato l’effetto dello stress indotto dal viaggio verso la clinica e dall’effetto “camice bianco” su quosti due analiti urinari nel cane.
Il livello di stress dei 36 cani sottoposti allo studio è stato valutato arbitrariamente dai rispetto proprietari ed è risultato via via più alto (Casa>Viaggio>Ospedale veterinario).
I campioni di urine sono stati ottenuti mediante minzione spontanea sa a domicilio che in clinica. Mentre i valori di proteinuria, misurati mediante il consueto rapporto PU/CU, non sono risultati significativamente differenti nei due prelievi, la cortisoluteria risultava significativamente augmentata nei campioni raccolti in clinica.
Il
circa di questi risultava addirittura magiore del normale intervallo di riferimento per la cortisoluria del cane. Questo aumento della cortisoluria indotto dal viaggio e dall’ambiente ospedaliero, non era infine correlibile a variazioni della proteinuria. Il principale limite dello studio, era legato al fatto che la maggior parte dei cani arruolati non erano francamente proteinurici.
Questi risultati dovrebbero ulteriamente sottolineare l’importanza della raccolta di urina a domicilio, qualora sia necessario valutare possibili stati di iperadrenocorticismo, che potrebbero essere falsamente diagnosticati in caso di urine raccolte in clinica (falso positivo dovuto allo stress).
Walter Bertazzolo, Direttore Scientifico di MYLAV

Come vanno utilizzati ed interpretati i test per la diagnosi di filariosi cardiopolmonare nel cane? Facciamo il punto della situazione con le attuali conoscenze scientifiche.
In questa prima parte parleremo in particolare dei test antigenici su sangue periferico e della loro reale accuratezza diagnostica.
I test antigeni per la diagnosi di filariosi cardiopolmonare,或者其他 rapi di facile esecuzione, sono considerati molto affidabili perché in grado di rilevareanche piccole concentrazioni di antigeni parassitari circolanti. Gli antigeni vengono liberati solo dai parassiti adulti (quindi almeno 6 mesi dopo l’infestazione),principalmente delle macrofilarie femmine (specialmente gravide) e in concentra
zioni molto più basse dai maschi. In presenza di un sospetto clinico fondato sono spesso indispensablei per arrivare a una diagnosi definitiva, ma sono molto utili although screening èsendo dotati di Sensibilità e Specificità molto elevate, che in quasi tutti i test in commercio si attesta attorno al 98% per entrambi i valori.
La sensibilità di un test è la sua capacité di identificare correttamente gli animali malati e risponde alla domanda: “quanti, degli animali malati sottoposti al test, sono positivi?”. In termini di probabilità, la Sensibilità è la probabilità che un animale malato risulta positivo al test o la proportione di animali malati che risultano positivi al test.
La Specificità di un test è la sua capacité di identificare correttamente gli animali sani. Risperpondendo alla domanda: “quanti, degli animali sani sottoposti al test, sono negativi?” In termini di probabilità, la Specificità è la probabilità che un animale sano risulta negativo al test o la proportione di animali sani che risultano negativi al test. Fino a non molto tempo fa la specificità dei test antigenici per D. immitis era considerata essere del 100%. Da quale tempo tuttavia sono ben note possibilità di false positività ascrivibili a reazioni crociate con altri parassiti. Angiostrongylus vasorum, Spirocerca lupi, Dirofilaria repens in primis, ma potenzialmenteanche altre specie di nematodi (come Acantocheilonema dracunculoides e Dracunculus medinensis) e cestodi.
Da un punto di vista clinico è importante ricordarsi, quando si valuta il risultato di un test, quali sono i loro valori di Sensibilità e Specificità. In genere sono dichiarati dal produttore e/o sono dati pubblicati da studi sull’argomento, e dovrebbero quando essere noti prima dell’applicazione del test sulla popolazione in esame.
Al clinico perché, interesssa probabilitmente molto di più rispondere alla seguenti domande:
Per poter rispondere a queste due domande, è necessario prendere in considerazione il Valore Predittivo, ovvero la probabilità che un soggetti positivo ad un test di screening sia effettivement affetto da那一 della patologia in esame (Valore Predittivo Positivo, VPP), oppure viceversa, che uno negativo al test sua veramente non affetto alla malattia in esame (Valore Predittivo Negativo, VPN).
Il problema più grande dei Valori Predittivi, è che a partir di test diagnostico e di performance ben stabilite in termini di Sensibilità e Specificità,ffi”Inceve variano in base alla prevalenza della patologia in quella specifica popolazione in esame: in sostanza in una popolazione dove la prevalenza della filariosi è elevata, un valore positivo al test è molto più probabile che sia un Vero Positivo che un Falso Positivo. Viceversa in una popolazione con bassa prevalenza della filariosi, la probabilità di un Falso positivo è nettamente più alta. La comprenzione di但这a relazione è facilitata da tabella sottostante che evidenzia,utilizzando un test antigenico con Sensibilità e Specificità del
,i diversi Valori Predittivi in relazione alla prevalenza della Filariosi.
Prevalence | Positive Predictive Value | Negative Predictive Value |
0.5 | 33.22% | 99.99% |
1.0 | 50.00% | 99.99% |
1.5 | 60.12% | 99.98% |
2.0 | 66.89% | 99.98% |
2.5 | 71.74% | 99.97% |
3.0 | 75.38% | 99.97% |
4.0 | 80.49% | 99.96% |
5.0 | 83.90% | 99.95% |
6.0 | 86.34% | 99.94% |
7.0 | 88.17% | 99.92% |
Come si più osservare, il Valore Predittivo Positivo in corso di screening in un’area con prevalenza di Filariosi cardiopolmonare vicina all’
, in caso di positività del test è circa del
. Ossia la probabilità che sia un Vero Positivo o un Falso Positivo sono
e
essendo la percentuale di veri positivi sovrapponibile alla percentuale attesa di falsi positivi al test.
Per incrementare il Valore Predittivo Positivo del test antigenico, è consigliabile eseguire contemporaneamente un altro test biologicamente diverso, che si basi,cisione su altra metodologia diagnostica. Nel caso della Filariosi cardiopolmonare il test di Knott. Un eventuale positività al test di Knott CONFermerebbe al
la diagnosi.
Per quello motivo le linee Guida ESDA (European Society of Dirofilariosis and Angiostrongylosis) e AHS (American Heartworm Society), raccomandano di eseguire sempre contemporaneamente i 2 test per incrementarne i Valori Predittivi Positivi e Negativi.
Altri test quali PCR su sangue non trovano applicazione in quello contesto. La PCR ricerca il DNA contento nelle microfilarie circolanti (gli adulti non eliminano DNA ma solo antigeni), con una sensibilità molto più Bassa rispetto al test di Knott, poché esamina volumi ematici circa 5 volte inferiori. In caso di microfilaremie con livelli di microfilarie pari o inferiori a 5-6 larve/ml è molto spesso falsamente negativa. Non ha alcun senso quando eseguirla in caso di negatività al test di Knott.
Qualora non sia possibile eseguire un test di Knott, puressoendo molto simplice, rapido ed economico, è possibile effettuare la ricerca ed identificazione morfologica delle microfilarie con valutazione di uno striscio ematico con colorazione rapida (Romanowsky), che presenta sensibilità e specificità, se l’identificazione morfolologica è effettuata correttamente, paria a quella della PCR ma con costi decidamente inferiori.
In conclusione i test antigenici per Dirofilaria immitis sono fondamentali per la diagnosi ma devono essere interpretati in relazione al loro uso. In caso di positività non comportata da un dato anamnestico (area a bassa prevalenza, proprietari che hanno effettuato chemioprofilassi, soggetti vicini ai 6 mesi di età), di lavoratorioio (Test di Knott negativo) o di diagnostica strumentale (mancata visualizzazione di macrofilarie in corso di ecocardiografia), prima di emettere una diagnosi e ancOR più effettuare un trattamento, è indispensable escludere false positività legate a reazioni crociate, in primis da Angiostrongylus vasorum e Dirofilaria repens.
Parleremo più di filariosi nella prossima puntata del nostro blog, a presto.
Luigi Venco, Dipl. EPVC, Esperto MYLAV
State esuguendo un test di stimolazione con ACTH e avete deciso di farlo per via EV, ma al momento di iniettarlo, vi accorgete che il farmaco è uscito nel sottocute e nei tessuti perivascolari.
Questa eventualità può capitare a chiunque decide di fare l’iniezione di ACTH per via endovenosa. La domanda che sorge spontanea a chiunque è: dovrò quando rifare il test, perché non posso essere certo dell’assorbimento adeguato dell’ormone e quando dell’affidabilità del test. Oppure no?
Dato che questo piccolo inconvenientmente è capitato proprio ad un cane di amici, mi sono interessato all’argomento. Ecco casa ho riscontrato.

In un articolo pubblicato sul Journal of Veterinary Internal Medicine (Johnson et al; Effect of intravenous or perivascular injection of syntetic ACTH on stimulation test in dogs; JVIM 2017), gli autori hanno studiato l’effetto di una corretta somministrazione endovenosa di ACTH con una in sede perivascolare. Lo studio è stato condotto su 10 cani sani e 10 cani con sindrome di Cushing in fase di monitoraggio terapeutico. Tutti i cani hanno effettuato il test di stimolazione con ACTH con entrambe le metodiche di somminastrazione (endovenosa e perivascolare), a distance di alcuni giorni una dall’altra.
Ebbene la modalità di somministrazione dell’ACTH non ha avuto alcun effetto significativo sui risultati del test. Possiamo quando aftermare che, in caso di erre di somminastrazione endovenosa, potete considerare affidavitibili comunique i risultati del test di stimolazione che avete effettuato.
Walter Bertazzolo, Direttore Scientifico di MYLAV Federico Fracassi, Esperto MYLAV di endocrinologia
La diagnosi definitiva delle neoplasie surrenaliche, necessita purtroppo una valutazione istologica. Gli aspetti clinici, i dosaggi ormonali e i riliev di diagnostica per immagini possono ovviamente indirizzare verso un incidentaloma non secernente, un tumore secernente adrenocorticale, un feocromocitoma o una metastasi. Tuttavia la conferma definitiva richiede una biopsia. L’esame citologico ha dimostrato una elevata accuratezza nella distinzione di neoplasie corticali VS midollari. Ma quando è rischioso farlo?
Storicamente, l’esecuzione di biopsie citologiche (o peggio, mediante tru-cut) delle neoformazioni surrenaliche, è stato tacciato come procedura molto rischiosa. In molti libri di oncologia clinica veterinaria viene altiamente sconsigliato. Ciò derives da esperenze della medicina umana, che hanno registrato eventi avversi molto gravi e talora fatali, nei casi in cui la massa campionata fosse un feocromocitoma. Queste complicazioni possono andare dal dolore post-FNA, a fenomeni emorragici più o meno gravi, fino a shock, difficoltà respiratoria, crisi ipertensive e morte. Se si valuta tuttavia la letteratura in maniera critica, si rileva come questi dati derivino in realità solo da sporadici case-report più che da studi più solidi.
L’esame citologico delle neoformazioni surrenaliche d’altra parte ha dimostrato una elevata accuratezza (90-100%) nella distinzione tra proliferazioni corticali (imagine in alto) e midollarii-feocromocitoma (immagine in basso). Sebbene non permetta con certezza di differenziarne forme maligne da benigne, il conoscere anticipatamente se una neoplasia sia corticale o midol

lare, permette al clinico di prendere possibili precazioni in caso di chirurgia, che potrebbe scatenare crisi ipertensive nel caso di un feocromocitoma.
In un recentissimo articolo pubblicato sul Journal of Veterinary Internal Medicine (Pey et al; Safety of percutaneous ultrasound-guided fine-needle aspiration of adrenal lesions in dogs: perception
of the procedure by radiologists and presentation of 50 cases; JVIM 2020), gli autori hanno cercato di valutare quale fosse la percezione del rischio di tale procedura da parte dei radiologi Board-certified al college Europeo o Americano.
Un totale di 138 radiologi hanno risposto al questionario: circa 2/3 dei radiologi ha risposto di non effettuare la procedura in quanto ritenuta troppo rischiosa o non utile ad aggiungere informazionivantaggiose per la gestione del caso clinico.
Per i radiologici che”Invece hanno risposto di effettuare più o meno regolarmente il campionamento, è stato registrato un tasso di complicanze dell’
(in prevalenza emorragie di grado moderato), di cui solo il
gravi, con morte del paziente il giorno successivo all’aspirazione. Tuttavia, il solo cane deceduto sembra che abbia avuto un outcome sfavorevole a causa di una paralisi laringea. Nessuna crisi ipertensiva è stata registrata.after I’FNA. Le dimensioni dell’ago o la tipologia di prelievo (aspirazione VS infissione) non hanno lostrato differenze in termini di rischio.
Compressivamente lo studio conferma quanto gli recentamente pubblicato in un’alto lavoro (Sumner et al. Clinical safety of percutaneous ultrasound-guided fine-needle aspiration of adrenal gland lesions in 19 dogs. J Small Anim Pract.
2018), in cui sono state osservate complicazioni post-FNA in 1 su 23 campionamenti citologici surrenalici.
Questa incidenza non è in sostanza molto diversa a quella osservabile in campionamenti di altri organi intra-cavitari.
Indipendente dell’utilità che possa averi il risultato della citologia ed il suo impatto sulla gestione del caso clinico, sulla quale non esiste più un accordo tra i clinici/endocrinologi, la procedura di FNA delle masse surreneliche del cane cui poè pertanto essere considerata non più rischiosa di altre.
Walter Bertazzolo, Direttore Scientifico di MYLAV
La PARR è una tecnia molecolare recentemente sviluppata in medicina veterinaria, per la diagnosi di neoplasia linfoode o di condizione reattiva: facciamo il punto della situazione con questo aggiornamento dei nostri esperti.
La diagnosi differenziale tra una malattia linfoide reattiva e neoplastica nel cane e nel gatto cui è essere complicata in alcuni pazienti e, data la diversa prognosi e trattamento, una diagnosi corretta diventa spesso cruciale. Il test di clonalità (PARR), che valuta la variabilità del riarrangimento genico dei recettori dell’antigene linfocitario, cui è essere un valido strumento per integrare l’interpretazione citologica, istologica ed immunoistochimica, allorquando questo non risultino conclusive.
Cerchiamo di fare un po’ di chiarezza sulla metodica e un aggiornamento rispetto ad un nostro precedente post su questo blog.
È una tecnia di biologia molecolare (PCR) atraverso cui si analizzano i riarrangiamenti genici delle cellule linfoidi a livello delle regioni VDJ dei geni delle immunoglobuline (IG) dei linfociti B e del recettore specifico dei linfociti T (T-Cell Receptor).
I geni delle IG e del TCR contengono diversi segmenti genici V, D, e J che vengo riarrangiati in modo casuale durante le fasi iniziuali del processo di crescita e differenziazione dei linfociti, conferendo una grande variabilità genetica, al fine di garantire un’elevata capacité da parte dei recettori dei linfociti B e T di riconoscere l’antigeni molto differenti.
PARR è l’acronimo di “PCR for antigen receptor rearrangements”.
Il test di clonalità si esegue utilizzando il DNA genomico estratto da tessuti fissati in formalina e inclusi in paraffina per l’esame istologico. Inoltre, cui quere essere ottenuo da preparati citologici,anche colorati, e versamenti. Il tessuto fresco o congelato rappresenta un substrato adeguato.
Si. Il DNA genomico estratto dai preparati citologici e dai versamenti è spesso scarso e di Bassa qualità. Inoltre, le cellule linfoidi presenti nel campione citologico possono non essere rappresentative dell’intera lezione, causando un erre interpretativo della PARR (soprattutto falsi negativi). In linea generale, non si consiglia di eseguire la PARR su preparati citologici e versamenti, soprattutto alla immunofenotipizzazione. I campioni inviati per l’esame istologico, di solito maggiorniente rappresentativi della lezione, sono inceve più adeguati per quello tipo di analisi.
In teoria, permette di distinguere tra processi reattivi/inflammatori a componente linfocitaria (policlonali) e processi neoplastici linfoidi (monoclonali).
No, per definizione i risultati della PARR (profili di elettroforesi) non sono mai diagnostici o patognomonici di un processo specifico e devono essere sempre interpretati insieme ai dati clinici, morfologici (istologia-citologia) e immunofenotipici (immunoistochimica-citofluorimetria). Pertanto, il solo test di clonalità non è definitivo.
No, la PARR non dovrebbe essere considerata come tecnica diagnostica principale per determinare il fenotipo (B o T). Altri strumenti, come la citofluorimetria, l’esame immunoistochimico e l’esame immunocitochimico sono i test indicati per determinare il fenotipo di una neoplasia linfofoide.
Posso richiedere la PARR dopo un’adeguata raccolta di dati clinici-anamnestici, campionamento/i per esame citologico ed istologico ed esame immunoistochimico. Il lavoratorio, essendo più in possesso del campione di tessuto in paraffina, pourrait eseguire la PARR a seguito della richiesta di aggiunta esame.
I profili di elettroforesi sono classificati in diverse categorie rappresentate da schemi archetipici (Figure 1-4):

CLONALE
Figura 1 - Esempio di amplificato monoclonale delle dimensioni attese.

POLICONALE
Figura 2 - Esempio di amplificati pollicionali multipli e di piccole dimensioni.
PSEUDOCOLONALE
Replica 1
Figura 3 - Esempio di amplificati monoclonali non ripetibili in due diverse amplificazioni (uno di 137 pb e l’alto di 115 pb).
Replica 2

NESSUN PRODOTTO SPECIFICO
Figura 4 - Esempio di amplificato negativo (non si osservano prodotti di amplificazione).
Diversi aspetti tecnici e biologici influiscono su sensibilità e specificità della PARR, dando esito a risultati negativi, falsi positivi o formazione di prodotti pseudoclonali. Nelle immagini schematiche seguenti sono elencate le cause principali:

Michele Marino, Biologo Molecolare di MYLAV
Luca Aresu, Patologo, Esperto MYLAV
Walter Bertazzolo, Direttore Scientifico di MYLAV
In oncologia, la valutazione istologica dei margini di escissione chirurgica è fondamente per il corretto iter terapeutico e per la prognosi. Per essere valutati accuratamente, ci deve essere una stretta collaborazione tra clinico/chirurgo oncologo e patologo. Ai primi spetta il compito di eseguire appropriamente la procedura chirurgica e segnalare correttamente i margini di escissione, ai secondi invece di processare il campione con procedure standard variabili da caso a caso. Ne parliamo approfonditamente in quello post.
L’esame istologico per la valutazione dei marginini chirurgici risultta essere un ausilio fondamentale per il clinico, in quanto permette di stabilire se la neoplasia sia stata escissa in todo o meno. Nel caso in cui i marginini risultino infiltrati, è importante stabilire dove si estenda la neoplasia e procedere, ove possibile, con “curettage” chirurgico o ulteriori interventi terapeutici mirati (es. radioterapia). Affronteremo l’argumento con I’ausilio di alcuni esempi pratici e disegni schematici.
I margini chirurgici dei tumori cutanei asportati in toto vengono sempre valutati in anni sezione istologica disponibile. Tuttavia la misura dell’estensione della neoplasia è limitata solo alle duesezioni trasversali che vengono preparate per ottenerà la diagnosi (tecnia del cross sectioning - fig. 1). Al contrario, la valutazione dei margini completinga si ottieneattraverso l’esame di tutto il margine perimetrale del campione ottenuto con l’exeresi chirurgica, ma risulta essere un processo più complesso e costoso, da richiedersi in fase di accettazione al laboratorio (tecniche dei margini perimetrali- fig.
, e di bread Bologna slicing - fig. 2B).

Figura 1 - Tecnica del sectioning.


Figura 2 - In alto, margini tangenziali /perimetrali; in basso, tecnica bread Bologna slicing.
Come possiamo segnare il margine chirurgico nel campione istologico inviato al laboratorio? Posso sono essere utilizzate diversi approcci:

Figura 3 - Margine di escissione identificato dall’inchiostro chirurgico all’esame istologico.
I margini contrassegnati dovranno essere segnalati accuramente sulla schedà di richiesta inviata al laboratorio.
Di seguito le modalità di studio dei marginini chirurgici in altri distretti, organi e apparati.
Come si osserva in figura 4, l’amputazione digitale prede, in fase di trimming, due passaggi:

Figura 4 - Margini a carico del dito (a sinistrasezioni dei tessuti molli, a destrasezioni post-decalcificazione).

È opportuno utilizzato l’inchiostro sulla faccia marginale cutanea o del canale au-ricolare.

Figura 5 - Margini a carico del padiglione auricolare/orecchio.

Prima del processo di decalcificazione, se possibile, si esegue una sezione della neoformazione. In seguito, si analizzano i margini ossei cranio-mediali e caudali con una sezione parallela e si esegue una sezione totale della parte comprehende la massa (fig.6).
È opportuno utilizzato l’inchiostro a livello dei margini caudali e mediali del pezzo operatorio.

Figura 6 - Margini per mandibolectomia/maxillectomia.
L’esame dei margini di rezezione intestinali (o di organi cavi tubulari) comprende una sezione parallela di ciascuno dei margini chirurgici (prossimale e distale) e una o piùsezioni della neoformazione (fig. 7). In questo caso non è necessario l’utilizzo di inchiestro ma un punto di sutura su uno dei margini (prossimale o distale, da identificare sulla schedà di accompagnamento) per l’orientamento del pezzo operatorio.

Figura 7 - Margini di organi cavi.
Anche nel caso degli organi parenchimatosi l’esame dei marginini viene eseguitoattraverso una sezione parallela dei marginini chirurgici e una o, se necessario, piùsezioni della neoformazione (fig. 8).
È opportuno utilizzare l’inchiostro sul margine di escissione (freccia blu in figura) per una più precisa valutazione marginale.

Figura 8 - Organi parenchimatosi.
Il patologo nel suo report finale, infine, inserisce l’entità del margine pulito nella descrizione, specificando (dove possibile) la misura in mm. Recentamente Liptak et al (2020) hanno proposto lo schema R utilizzato in medicina umana, il quale definisce diversi gradi di infiltrazione dei marginini. Tuttavia tale schema classificativo deve ancora essere validato in medicina veterinaria:
![]()
R0>1mm
R0 (un)
R1 (is)
R2a, R2be R2c
dove R0 è esente, R0 (un) si riferisce ad un’escissione istologica completa ma con stadiazione clinica incomplete, R1 (is) è la presenza di tumore in situ al margine chirurgico e R2a, R2b e R2c identificano una malattia locale residua, malattia metastatica residua e malattia residua in entrambi i siti (Liptak 2020)
Selina Iussich & Luca Aresu - Università di Torino
Kamstock, D. A., Ehrhart, E. J., Getzy, D. M., Bacon, N. J., Rassnick, K. M., Moroff, S. D., Kiupel, M. (2010). Recommended Guidelines for Submission, Trimming, Margin Evaluation, and Reporting of Tumor Biopsy Specimens in Veterinary Surgical Pathology. Veterinary Pathology, 48(1), 19-31.
Liptak, J. M. (2019). Histologic Margins and the Residual Tumour Classification Scheme: Is It Time to Use a Validated Scheme in Human Oncology to Standardize Margin Assessment in Veterinary Oncology? Veterinary and Comparative Oncology.
DJ Meuten. Tumors in domestic animals. V edition. Wiley Blackwell, 2017
Milovancev, M., & Russell, D. S. (2017). Surgical margins in the veterinary cancer patient. Veterinary and Comparative Oncology, 15(4), 1136-1157.
L’esame tricoscopico è una metodica diagnostica utilizzata in dermatologia. Viene utilizzata per lo studio della struttura dei peli e per la valutazione di malattie che si presentano con alopecia. Vediamo nei dettagli come si esegue e a casa serve con il nostro esperto Federico Leone.
Per un corretto campionamento, i peli vanno afferrati alla base, in corrispondenza dell’emergenza dell’ostiofollicolare e strappati rispetto sempre il loro senso di crescita per evitare fratture che impediscano di estrarne la porzione follicolare.
Per l’estirpazione dei peli si utilizza una pinza emostatica Mosquito con le punte diritte o curve. É consigliabile ricoprire le branche della pinza con due tubicini di gomma (può essere utilizzato anche il tubicino della butterfly), per evitare di danneggiare i peli e causare artefatti, e per ottenere, contemporaneamente, una presa migliorere sui fusti piliferi.

Figura 1 - Esempio di procedura di prelievo di peli per esame tricoscopico.
Alcuni clinici preferiscono prelevare i peli direttamente con le dita, stringendoli fermamente tra indice e pollice e utilizzando i guanti, soprattutto in caso di sospetto clinico di dermatofitosi.
É importante non strappare troppi peli alla volta per non causare fastidio all’animale.
I peli devono essere strappati energeticamente per essere sicuri di raccogliere un campione significativo in tutte le fasi del ciclo pilifero e non solo quelli in fase di riposo che si sfilano più facilmente, in quanto lassamente anticorati al follicolo.
Se si sospetta una dermatofitosi, si hanno maggiori possibilità di successo includendo nel preparato i peli risultati fluorescenti con la lampada di Wood.
Per inviarli al laboratorio, i peli vanno inserti in una busta di carta da lettera per permettere all’operaatore di raccoglierli confacility. Va evitato il materiale in plastica, in quanto rende dificile la raccolta dei peli che tendono ad aderire alla superficie di plastica del contentitore.
L’esame tricoscopico permette di valutare la fase del ciclofollicolare, le alterazioni morfologico-strutturali dei peli e la presenza di parasiti e di dermatofiti.

Figura 2 - Esame tricoscopico di un cane con alopecia diffusa: aggregato di melanosomi che deforma il fatto pilifero.
Lo studio delle radici permette di valutare la presenza di un’alterazione del rapporto anagen/telogen (come si verifies nelle endocrinopatie, nel deflusso telogeno o nell’alopecia post tosatura) o una quantità eccessiva di materiale cheratinico (come si osserva nei disturbifollicolari o nei disturbi della cheratinizzazione come, ad esempio l’adenite sebacea).
Le radici possono essere malformate, unitamente al fusto pilifero, per alterazioni della pigmentazione (come si osserva nell’alopecia del mantello diluito o in那一 delle peli neri).
Il fusto pilifero cui oappare destrutturato per la presenza di ife fungine e circa- to da spore fungine in corso di dermatofitosi.

Figura 3 - Esame tricoscopico di un gatto con alopecia facale: artroconidi che avvolgono unello infetto.
Altre malattie rare del fusto pilifero diagnosticabili con l’esame tricoscopico sono la tricomalacia, la tricoressi nodosa e i pili torti.
Le punte possono apparire spezzate come si verifica classicamente per autotraumatismo (prurito allergico o parassitario) o alterate in seguito ad excessiva esposezione ad agenti atmosalferici.
Con l’esame tricoscopico è possibile infine evidenziare la presenza di Demodex, uova di Cheyletiella e adulti e uova di pidocchi.

Figura 4 - Esame tricoscopico di un cane con alopecia multifocale: numerousi adulti di Demodex canis.

Figura 5 - Esame tricoscopico di un gatto con alopecia rarefazione del mantello: uovo di pidocchio (lendine) adesa al fusto pilifero.
Federico Leone, Esperto MYLAV in dermatologia
Il mastocitoma cutaneo a localizzazione dermica è una delle neoplasie più frequenti del cane. Con il progressivo incremento delle evidenze scientifiche, l’approccio a但这a patologia neoplastica è cancellato decisamente nel corso degli ultimi anni. Cosa è davvero necessario fare e come dobbiamo comportarci in base a stadio clinico e grado istologico?

Vi diafo le attuali linee guida.
La nostra consulente in oncologia, la prof. Laura Marconato (ECVIM-Oncology Diplomate) dell’università di Bologna, in collaborazione con il team di patologi di Mylav, ha redatto un documento dettagliato ed un algoritmo splificato, che potete scaricare liberamente, nei quali vengono indicate le linee guida più attuali per la gestione del mastocitoma dermico del cane. Con l’esempio dei vari scenari possibili, vi verranno indicate quali sono le indagini aggiuntive eventualmente consigliate e le terapie adiuvanti. Dobbiamo sottolineare che queste linee guida non sono
adatte ai mastocitomi con localizzazione sottocutanea, di cui vi parleremo invece nel prossimo post.
Alla luce delle conoscenze attuali, “mastocitoma” è una diagnosi generica. La maggior parte dei mastocitomi del cane coinvolge il derma, e viene gradato istologicamente secondo quando descririto da Patnaik (1984) e più recentamente da Kiupel (2010).

Una parte minoritaria coinvolgerieve esclusivamente il sottocute: in quello caso non si applica alcun grading.
I mastocitomi muco-cutanei rappresentano-inverse una categoria a sé e, parimenti ai sottocutanei, non vengono gradati.
Il grado istologico, sebbene molto importante per definire la prognosi, delve essere integrato con il dato dello stadio clinico. A quello proposito, è stato documentato che la linfadenectomia, eseguita contestualmente alla rimozione del tumore primitivo, non solo ha un importante ruolo diagnostico, ma haanche un ruolo terapeutico. Per
questo motivo è importante che il linfonodo regionale venga identificato e rimioso, indipendenteamente delle sue dimensioni e alla diagnosi citologica, e inviato insieme al mastocitoma primitivo in laboratorio, per il corretto inquadramento patologico.
Mettendo insieme: sede di origine + grado istologico + stadio clinico, è possible anticipare il comportamento biologico e stabilire se il cane ha bisogno, o meno, di terapie adiuvanti.
Oggi sono disponibili moltissimi marcatori e test, che possono essere richiesti in lavoratorio per perfezionare la diagnosi istopatologica e definite con maggiord precisione la prognosi.
Questa guida è intesa ad aiutare il clinico a orientarsi nella richiesta dei test aggiantivi. É da intendersi per canienza metastasi viscerali.
Voglio sottolineare che agli caso deve essere valutato in tutti i loro aspetti, ed è sostanto il veterinario curante ad averè il quadro complessivo.
SCENARIO 1 - Mastocitoma cutaneo di basso grado (1-2 Patnaik, low Kiupel), asportato con margini radicali. Linfonodo regionale rimioso e di stadio HN0-HN1-HN2 secondo Weishaar (2014).
La prognosi è buona/eccellenente, e la chirurgia è da considerarsi curativa. Non sono consigliati marcatori/analisi mutazionale, che possono tuttavia essere richiesti laddove si volesse una conferma definitiva della non aggressività biologica.
SCENARIO 2 - Mastocitoma cutaneo di basso grado (1-2 Patnaik, low Kiupel), asportato con marginini radicali. Linfonodo regionale rimioso e di stadio HN3 se- condo Weishaar.
Lo stadio HN3 per il linfonodo regionale indica la metastasi conclamata, ed è un fattore prognostico negativo. In quello caso, la chirurgia non può consi
derata curativa, ed è necessario ricorrere alla terapia medica (chemioterapia o inhibitori tirosin-chinasici). In quello caso il test più utile è l’esame mutazionale sui diversi esoni di c-kit: se è presente una mutazione attenuante (ad es, ITD), è possibile trattare il cane con farmaci anti-tirosin- chinasici. L’esame mutazionale può essere seguito sua sul tumore primitivo sua sul linfonodo metastatico (concordanza del 100%).
La valutazione immunoistochimica del pattern di espressione di KIT (CD117) ha valenza prognostica. La patologica localizzazione citoplasmatica di KIT (pattern 3) è significativamente associata alla presenza di mutazioni nel gene c-kit (che vanno comunque confermate mediante analisi genetiche, in quanto sono segnalati falsi positivi e falsi negativi). I mastocitomi che migliorano aberrante localizzazione immunoistochimica di KIT (pattern 2 o 3) hanno prognosi peggiore di quelli con pattern 1.
SCENARIO 3 - Mastocitoma cutaneo di basso grado (1-2 Patnaik, low Kiupel), asportato con marginini radicali. Stato del linfonodo regionale sconosciuto (non asportato).
Questa è una situazione di dificile gestione, perché manca lo step più importante dello staging. L’ideale sarebbe ritornare in chirurgia ed eseguire la linfadenectomía. Se non fosse possibile, i seguenti marcatori possono aiutare nel predire il comportamento biologico: immunoistochimica per Ki67 e KIT pattern, esame mutazionale.
La citologia del linfonodo regionale deve essere inclusa nella valutazione del caso.
SCENARIO 4 - Mastocitoma cutaneo di basso grado (1-2 Patnaik, low Kiupel), asportato senza margini radicali. Linfonodo regionale rimioso e di stadio HN0-HN1-HN2 secondo Weishaar.
Non tutti i mastocitomi di basso grado, asportati nella radicalità, recidivano. Pertanto la radicalizzazione chirurgica oppure la radioterapia adiuvante non trovano sempreindicazione. A questo proposito ci aiuta il marcatore Ag67 (che deriva dal prodotto AgNor e Ki67): se
, il rischio di recidiva locale è elevato, ed in quello caso è prudente ricorrere ad una terapia adiuvante (seconda chirurgia, radiotera
pia). Gli altri marcatori immunoistochimici (Ki67 e pattern KIT), se valutati insieme, aiutano a valutare il rischio di recidiva locale. Il test mutazionale,invece non è utile, poiché non è individata la terapia medica.
SCENARIO 5 - Mastocitoma cutaneo di basso grado (1-2 Patnaik, low Kiupel), asportatoenza margini radicali. Linfonodo regionale rimioso e di stadio HN3 secondo Weishaar.
I problemi sono due: mancato controlo locale e presenza di metastasi nodali.
Per il controllo locale, vale quanto riportato nelle scenario 4. Essendo il linfonodo metastatico, è individata la terapia medica, pertanto l’analisi mutazionale è utile per la scelta terapeutica.
SCENARIO 6 - Mastocitoma cutaneo di basso grado (1-2 Patnaik, low Kiupel), asportato senza margini radicali. Stato del linfonodo regionale sconosciuto (non asportato).
Manca il controllo locale, ma come gli detto, il margine non radicale non indica necessariamente la recidiva. In quello scenario è indicato richiedere Ag67, Ki67 e pattern KIT per anticipare un comportamento biologico più aggressivo, e quando un maggior rischio di recidiva.
La citologia del linfonodo regionale deve essere inclusa nella valutazione del caso. L’ideale sarebbe comunque tornare in chirurgia per asportare il linfonodo regionalale e quindianche radicalizzare la ferita chirurgica.
SCENARIO 7 – Mastocitoma cutaneo di alto grado (3 Patnaik, high Kiupel), asportato con margini radicali. Stato del linfonodo regionale da HN0 a HN2. Non esistono chiareindicazionicirca l’utilizzo di terapia medica;secondo alcuni studi è pridente consigliarla. In quello caso, è ideale richiedere l’analisi mutazionale.
SCENARIO 8 – Mastocitoma cutaneo di alto grado (3 Patnaik, high Kiupel), aspor-tato con margini radicali. Stato del linfonodo regionale HN3.
La terapia medica è indicata: richiedere l’analisi mutazionale.
SCENARIO 9 – Mastocitoma cutaneo di alto grado (3 Patnaik, high Kiupel), aspor-tato除去 marginini radicali. Stato del linfonodo regionale HN0-HN3.
Il comportamento biologico è aggressively, soprattutto se il linfonodo è di stadio istologico HN3. La terapia medica è indicata: richiedere pertanto l’analisi mutazionale.
Solitamente i mastocitomi di alto grado asportati nella radicalità tendono a recidivare, e iMarcatori in quello caso non aggiungono informazioni utili ai fini della gestione clinica.
SCENARIO 10 - Mastocitoma cutaneo di alto grado (3 Patnaik, high Kiupel), asportato con margini radicali. Stato del linfonodo regionale sconosciuto (non asportato).
L’asportazione del linfonodo regionale migliorara la prognosi ed è suggerita. Si consiglia di richiedere l’analisi mutazionale.
SCENARIO 11 - Mastocitoma cutaneo di alto grado (3 Patnaik, high Kiupel), asportatorawnargini radicali. Stato del linfonodo regionale sconosciuto (non asportato).
L’asportazione del linfonodo regionale migliorara la prognosi ed è suggerita. Si consiglia di richiedere l’analisi mutazionale.
Solitamente i mastocitomi di alto grado asportati nella radicalità tendono a recidivare: i marcatori in quello caso non aggiungono informazioni utili ai fini della gestione clinica.
Ferrari R, Marconato L, Buracco P, Boracchi P, Giudice C, lussich S, Grieco V, Chiti LE, Favretto E, Stefanello D. The impact of extirpation of non-palpable/normal-sized regional lymph nodes on staging of canine cutaneous mast cell tumours: A multicentric retrospective study. Vet Comp Oncol. 2018Dec;16(4):505-510.
Kiupel M, Webster JD, Bailey KL et al. Proposal of a 2-tier histologic grading system for canine cutaneous mast cell tumors to more accurately predict biological behavior. Vet Pathol. 2011 Jan;48(1):147-55.
Marconato L, Polton G, Stefanello D, Moreno E, Ferrari R, Henriques J, Tortorella G, Benali SL, Bergottini R, Vasconi ME, Annoni M, Sabattini S. Therapeutic impact of regional-lymphadenectomy in canine stage II cutaneousmastcelltumours. Vet Comp Oncol. 2018 Dec;16(4):580-589.
Marconato L, Stefanello D, Kiupel M, Finotello R, Polton G, Massari F, Ferrari R, Agnoli C, Capitani O, Giudice C, Aresu L, Vasconi ME, Rigillo A, Sabattini S. Adjuvant medical therapy provides no therapeutic benefit in the treatment of dogs with low-grade mast cell tumours and early nodal metastasis undergoing surgery. Vet Comp Oncol. 2020 Jan 12. doi: 10.1111/vco.12566.
Marconato L, Zorzan E, Giantin M, Di Palma S, Cancedda S, Dacasto M. Concordance of c-kit mutational status in matched primary and metastatic cutaneous canine mast cell tumors at baseline. J Vet Intern Med. 2014 Mar- Apr;28(2):547-53.
Moore AS, Frimberger AE, Taylor D, Sullivan N. Retrospective outcome evaluation for dogs with surgically excised, solitary Kiupel high-grade, cutaneous mast cell tumours. Vet Comp Oncol. 2020 Jan 9. doi: 10.1111/vco.12565.
Patnaik AK, Ehler WJ, MacEwen EG. Canine cutaneous mast cell tumor: morphologic grading and survival time in 83 dogs. Vet Pathol. 1984 Sep;21(5):469-74.
Sledge DG, Webster J, Kiupel M. Canine cutaneous mast cell tumors: A combined clinical and pathologic approach to diagnosis, prognosis, and treatment selection. Vet J. 2016 Sep;215:43-54.
Smith J, Kiupel M, Farrelly J, Cohen R, Olmsted G, Kirpensteijn J, Brooks B, Post G. Recurrence rates and clinical outcome for dogs with grade II mast cell tumours with a low AgNOR count and Ki67 index treated with surgery alone. Vet Comp Oncol. 2017 Mar;15(1):36-45.
Stefanello D, Buracco P, Sabattini S, Finotello R, Giudice C, Grieco V,lussich S, Tursi M, Scase T, Di Palma S, Bettini G, Ferrari R, Martano M, GattinoF, Marrington M, Mazzola M, Elisabetta Vasconi M, Annoni M, Marconato L. Comparison of 2- and 3-category histologic
grading systems for predicting the presence of metastasis at the time of initial evaluation in dogs with cutaneous mast cell tumors: 386 cases (2009-2014). J Am Vet Med Assoc. 2015 Apr1;246(7):765-9.
Thamm DH, Avery AC, Berlato D, Bulman-Fleming J, Clifford CA, Hershey AE, Intile JL, Jones PD, Kamstock DA, Liptak JM, Pavuk A, Peauroi J, Powell R, Rissetto K, Valli VEO, Webster JD. Prognostic and predictive significance of KIT protein expression and c-kit gene mutation in canine cutaneous mast cell tumours: A consensus of the Oncology- Pathology Working Group. Vet Comp Oncol. 2019 Dec;17(4):451-455.
Weishaar KM, Thamm DH, Worley DR, Kamstock DA. Correlation of nodal mast cells with clinical outcome in dogs with mast cell tumour and a proposed classification system for the evaluation of node metastasis. J Comp Pathol. 2014 Nov;151(4):329-38.
Luca Aresu, Università di Torino e Esperto MYLAV in patologia
Walter Bertazzolo, Direttore Scientifico di Mylav
Il mastocitoma sottocutaneo è una neoplasia meno freqente della contrapore. cutanea e per la quale abbiamo meno dati scientifici a dispositione. Pertanto non possiamo attualmenteindicare delle linee guida precise come per quello a localizzazione dermina.
Abbiamo cercato comunque di fornire delle indicazioni pratiche per il clinico, al fine di facilitare l’utilizzo dei test diagnostici aggiuntivi e delle eventuali terapie adiuvanti. Clinicamente i mastocitomi sottocutanei sono essere facilemente confusi con altre neoplasie benigne, come ad esempio i lipomi, e istologicamente si presentano come noduli o masse sottocutanee demarcate nella coinvolgimento del derma.
Al contrario dei mastocitomi dermici, i sottocutanei attualmente non vengono gradati istologicamente/citologicamente.

Sebbene i mastocitomi sottocutanei siano ritenuti a comportamento biologico più benigno, una parte di essi da metastasi e si comporta in modo aggressivo, soprattutto quelli a crescita infiltrante e con conta mitotica
HPF. Anche quello dato prognostico è tuttavia basato su evidenze scientifiche meno robuste di quando ad anni sappiamo sul mastocitoma cutaneo.
Questa guida è intesa per aiutare il clinico a orientarsi nella richiesta dei test aggiantivi, che possano fornire informazioni prognostiche ed un ausilio all’orientamento terapeutico. É da intendersi per cani sulla metastasi viscerali. Va rimarcato che leindicazioni che ho elencato nei diversi possibili scenari, sono il risultato di informazioni scientifiche meno robuste rispetto alla controparte cutanea, pertanto è possibile che nel prossimo futuro queeste linee guida possano venir modificate, con la disponibilità di nuovi dati in letteratura.
Voglio sottolineare infine che agli caso deve essere valutato in tutti i loro aspetti, ed è sostanto il veterinario curante ad ave il quadro complessivo.
La prognosi è buona/ eccellenente, e la chirurgia è da considerarsi curativa. Non sono consigliati marcatori/ analisi mutazionale, che possono tuttavia essere richiesti laddove si volesse una conferma definitiva della non aggressività biologica. Per i casi con conta mitotica
HPF o con pattern di crescita infiltrante, è prudente suggerire follow-up più frequenti.
Lo stadio HN3 per il linfonodo regionale indica la metastasi conclamata, ed è un fattore prognostico negativo. In quello caso, la chirurgia non può essere considerata curativa, ed è necessario ricorrere alla terapia medica (chemiaterapia o inibitori tirosinchinasici). In quello caso il test più utile è l’esame mutazionale sui diversi esoni di c-kit: se è presente una mutazione attenuante (ad es, ITD), è possibile trattare il cane con farmaci anti-tirosinchinasici. L’esame mutazionale può essere eseguito sua sul tumore primitivo sua sul linfonodo metastatico (concordanza del 100%).
Questa è una situazione di dificile gestione, perché manca lo step più importante dello staging. L’ideale sarebbe ritornare in chirurgia ed eseguire la linfadenctomia. Se non fosse possibile, i seguenti marcatori possono aiutare nel predire il comportamento biologico: Ki67, KIT pattern, esame mutazionale. La citologia del linfonodo regionale deve essere inclua nella valutazione del caso.
Non tutti i mastocitomi sottocutanei asportati nella radicalità recidivano. Pertanto la radicalizzazione chirurgica oppure la radioterapia adiovante non trovano sempre significare. A quello proposito, altri al pattern di crescita, ci aiutano: conta mitotica (cut-off 4), Ki67, Ag67, KIT pattern. Il test mutazionale”Invece non è utile, poiché non è individata la terapia medica.
I problemi sono due: mancato controlo locale e metastasi nodali. Per il controllo locale, vale quanto riportato nelle scenario 4. è indicata inoltre l’analisi mutazionale per la scelta terapeutica, dal momento che lo stadio HN3 per il linfonodo regionale indica la metastasi conclamata, ed è necessaria una terapia medica antitumorale.
Manca il controllo locale, ma come gli detto, il margine non radicale non indica necessariamente la recidiva. In quello scenario è indicato richiedere conta mitotica (cut-off 4), Ki67, Ag67, KIT pattern per anticipare un comportamento biologico più aggressivo, e quando un maggior rischio di recidiva. La citologia del linfonodo regionale deve essere inclusa nella valutazione del caso. L’ideale sarebbe comunque tornare in chirurgia per asportare il linfonodoregionale e quandoanche radicalizzare la ferita chirurgica.
Newman SJ, Mrkonjich L, Walker KK, Rohrbach BW. Canine Subcutaneous Mast Cell Tumour: Diagnosis and Prognosis. J. Comp. Pathol. 2007; 136, 231-239.
Thompson JJ, Pearl DL, Yager JA, et al. Canine subcutaneous mast cell tumor: Characterization and prognostic indices. Vet. Pathol. 2011; 48, 156-168.
Thompson JJ Yager JA, Best SJ, et al. Canine subcutaneous mast cell tumors: Cellular proliferation and kit expression as prognostic indices. Vet. Pathol. 2011; 48, 169-181.
Thompson JJ, Morrison JA, Pearl DL, et al. Receptor Tyrosine Kinase Expression Profiles in Canine Cutaneous and Subcutaneous Mast Cell Tumors. Vet. Pathol. 2015; 53, 545-558.
Weishaar KM, Thamm DH, Worley DR, Kamstock DA. Correlation of nodal mast cells with clinical outcome in dogs with mast cell tumour and a proposed classification system for the evaluation of node metastasis. J. Comp. Pathol. 151, 329-338 (2014).
Laura Marconato, Università di Bologna, Esperto MYLAV in oncologia Luca Aresu, Università di Torino, Esperto MYLAV in patologia Walter Bertazzolo, Diretto Scientifico di Mylav
Qual è l’attuale diffusione e prevalenza delle più comuni malattie trasmesse da vettori nei nostri animali da compagnia in Italia? Non è semplice dare una risposta ma abbiamo cercato di fornire un aggiornamento basandoci su dati attualmente pubblicati e disponibili in letteratura. Ce ne parla Luigi Venco, nostro consulente in Parassitologia.

Figura 1 - Hepatozoon canis.
È dificile valutare l’effettiva prevalenza dell’infezione dei diversi agenti patogeni trasmessi da vettori (CVBD - Canine Vector Borne Diseases) in cani e gatti in Italia, a causa della quantità limitata di dati e della difficoltà nel confrontare le in-
formazioni dagli studi basati su diversi strumenti diagnostici. Le prevalenze delle infezioni da agenti patogeni trasmessi da vettori variano inoltre in base alla regione geografica e alle diverse condizioni climatiche e del territorio.
Gli agenti eziologici che rivestono maggiore importanza per diffusione e implicazione cliniche sono, nel loro paese: Babesia spp., Ehrichia canis, Anaplasma platys, Anaplasma phagocytophilum, Dirofilaria immitis, Dirofilaria repens, Leishmania infantum ed Hepatozoon canis.
Esistono dati limitati sulla prevalenza delle infezioni da Babesia sp Nell’Italia centrale e settentrionale si osserva una siero-prevalenza media del
sulla base della ricerca di anticorpi anti-Babesia con una tendenza decrescente dalle aree centrali a quale settentrionali, con una maggiore predispositione per cani di canile o ètà tra i 25 e 48 mesi.
Indagini molecolare sulle diverse specie di Babesia spp. in campioni di sangue di cani con segni clinici compatibili, dimostrano che B. canis viene rilevato principalmente nel nord Italia, nelle B. vogeli è presente principalmente nella zona centrale e nell’Italia meridionale.
Babesia gibsoni in Italia,invece è riscontrabile con maggior frequenza nelle aree centro meridionali, in particolare in Campania.

A Babesia canis. B Babesia gibsoni. C Babesia vogeli.
Per quanto concerne Ehrlichia canis, la prevalenza stimata sulla base dei dati sierologici, varia dal
nel sud Italia al
in Sardegna, cioè la prevalenza complessiva valutata tramite Real time PCR è oviamente inferiore a quella indicata alla sierologia,indicando che l’infezione è più diffusa nel sud
che nel centro
e nel nord
Italia. Queste discrepanze sono dovute ai diversi metodi utilizzati in agli studio, maanche al fatto che il rischio di infezione da E. canis varia in base a fattori strettamente locali (ad es. popolazione vettoriale, densità e modelli di attività). Anaplasma platys è stato rilevato molecolarmente in Italia centrale
e meridionale
, spesso in associazione ad E. canis.除去 A. phagocytophilum in Italia meridionale
.

A Anaplasma phagocytophilum. B Anaplasma platys. C Ehrlichia canis.
Negli ultimi 20 anni. Dirofilaria immitis haizzato un rilevante aumento della prevalenza all’interno delle aree storicamente endemiche (22-80% nei soggetti non sottoposti a chemioprofilassi) e una diffusione al di fuori della principale area endemica della Pianura Padana, come nelle province dell’Italia nord-orientale precedentamente considerate non endemiche. Inoltre, D. immitis è divertata endemica nelle regioni centrali come la Toscana e l’Umbria.
Un recente studio condotto su cani del sud Italia ha verificato prevalenze di D. repens (1,4%) e D. immitis (0,5%) in Campania. Coinfezioni da D. immitis e D. repen sono state registrateanche in Puglia e Calabria, con tassi di prevalenza fino all’1,6%. La diffusione di D.repens nel nord Italia e nuovi focolai di D.immitis recentamente rilevati nelle regioni meridionali come la Sicilia, indicano che i cani sono a rischio sua per Dirofilaria immitis sua per D. repens in tutto il paese, se non sottomosti a misure profilattiche.
Per lungo tempo la Leishmaniosi canina (da Leishmania infantum) è stata considerata stabilmente endemica nell’Italia meridionale e centrale, e nelle aree litoranee del nord Italia, con tassi di siero prevalenza fino al 53,1%.
Sulla base di dati recenti inerenti la raccolta e l’identificazione di flebotomi, l’individuzione di casi autoctoni nel cane e di casi nell’uomo, nuovi focolai di Leishmaniosi canina sono stati individuiati nelle regioni settentrionali in cui la malattia era precedentamente considerata non endemica. Inizialmente nelle regioni collinari appenniniche ma attualmenteanche nella Pianura Padana, dove in seguito al cambiamento delle condizioni climatiche (aumento delle temperature invernali, scomparsa della nebbia), si verificano le condizioni per la sopravvenenza dei Flebotomi in diapausa nel periodo invernale. Sono di recentissima segnalazione nuovi focolai nel Piemonte e nel Triveneto, ma anche in Lombardia, con tendenza alla diffusione delle zone altre-padane a quella cis-padane nella provincia di Pavia e numerousi altri focolai nelle province di Bergamo, Brescia, Lodi, Milano e Cremona.
Anche per L. infantum i cani devono quindi essere considerati a rischio in tutto il paese.
Per quanto esistano segnalazioni di casi sporadici di Hepatozoon canis nell’Italia settentrionale, quello patogeno è riscontrabile con elevate prevalenze nel centro
e sud Italia, spesso in associazione a CVBD trasmesse da Riphicephalus sanguineus (ospite definitivo) che infetta il cane (ospite intermedio) non con il morso, matramite l’ingestione della zecca intera.

A Hepatoozon canis. B Leishmania infantum. C Dirofilaria immitis
Immagine tratte da Otranto D., Dantas Torres F “Prevalence of infection by vector-bornepathogens in cats and dogs in Italy” Parasites & Vectors 2010.
Di Luigi Venco, EBVS European Specialist
in Veterinary Parasitology (Dipl. EPVC), Esperto MYLAV.

Avete fatto un campionamento di midollo osseo perfetto per un esame citologico, ma”Invece che strisciarlo appropriatamente, lo avete preparato lasciandolo gocciolare sul vetrino per gravità (come nella foto seguente). Il risultato? avrete un campione non diagnostico.
Vi diaço alcuni consigli su come si deve fare la procedura corretta che porta a risultati valutabili come lostrato nella imagine seguente.

Figura 1 - Strisci di buona qualità e campione citologico ben interpretable.
Per una corretta interpretazione citologica, l’esame del midollo osseo richiede una adeguata qualità: gli aspetti microscopici sono interpretabili correttamente solo se il campione è rappresentativo ed è adeguatamente preparato (come nei due strisci a destra dell’immagine precedente). A tale fine i seguenti due punti cardine devono essere rigorosamente soddisfatti:

Figura 2 - Strisci di cattiva qualità ottenuiti per gocciolamento.
Riceviamo purtroppo ancora dei campioni non strisciati, ma preparati solo per gocciolamento, come nella foto precedente. Un campioneosi fissato risulterà ingiudicabile all’esame microscopico, in quanto troppo spesso e con sovrapposizione delle varie cellule, che non permetterà di ottenere una valutazione quali/quantitativa adeguata.
Ovviamente ci sono situazioni in cuianche un campionamento ed una preparazione perfetta, condurranno ad un campione non diagnostico, ma queste sono tendenzialmente legate a gravi patologie midollar in cui il tessuto ematopoietico è stato ampiamente rimpiazazzo da tessuto adiposo (es. aplasia midollare) o fibroso (es. mielofibrosi), come nell’imagine successiva. In questi casi purtroppo l’unica procedura in grado di fornirvi una diagnosi definitiva è la biopsia istologica midollar.
Walter Bertazzolo, EBVS European Specialist
in Veterinary Clinical Pathology (Dipl. ECVCP); Direttore Scientifico di MYLAV.
Nell’ultimo decennio l’American Animal Hospital Association e la American Association of Feline Practitioners hanno decidso di create delle linee guida per i medici veterinari, che li aiutassero ad individuire le procedure sanitarie più importanti da proporre ai proprietari di cani e gatti, al fine di salvaguardarne la salute di entrambi, focalizzando in particolare l’attenzione sull’ètà del paziente. Per agli fascia di età sono stati individui una series di punti critici su cui focalizzare gli interventi di prevenzione e cura dell’animale. Vediamo in nei dettagli casa è stato proposto per il cane. Nella prossima puntata vi daremoanche leindicazioni relative al gatto.

Cucciolo
Adultogiovane
Adultomaturo
Anziano
Nel 2012 l’American Animal Hospital Association (AAHA), in considerazione della crescente importanta che il cane ha assunto nella società e negli affetti dell’uomo, ha pubblicato le prime linee guida per la salvaguardia della salute del cane (Bartges et al., 2012). Linee guida che fanno seguito a quella pubblicate nel 2010 alla stessa AAHA in collaboratione con l’American Association of Feline Practitioners (AAFP) per il gatto (Vogt et al., 2010), e che sono state rivedute, aggiornate e riproposte sette anni dopo nella loro seconda edizione (Creevy et al., 2019). Una delle peculiarità di queste linee guida è quella di aver suddiviso la vita del cane in stadi,
non rigidamente definiti in termini escludivi di età, ma che tenessero conto sia di questo parametro che di altre caratteristiche (Tabella 1).
Tabella 1. Suddivisione della vita del cane in stadi. | |
Cucciolo | Dalla nascita alla cessatione della crescita rapida (6 anni - 9 anni, variabile con la razza e la taglia). |
Adulto giovane | Dalla cessatione della rapida crescita fino al completamento della maturazione fisica e sociale, che si verifica nella maggiore parte dei cani dai 3 ai 4 anni. |
Adulto matouro | Dal completamento della maturazione fisica e sociale fino all'ultimo quarto della durata stimata della vita (razza e taglia dipendente). |
Anziano | L'ultimo quarto della durata stimata della vita fino alla fine della vita stessa. |
Ultima fase di vita | Stadio terminale (dipendente delle specifiche patologie). |
Sebbene la suddivisione in stadi sua arbitraria, permette di identificare interventi individualizzati, specifici e adatti alle diverse esigenze che può averire il cane nei diversi momenti della sua vita. Al fine sono stateanche identificate dieci aree focalizzate di assistenza sanitaria (Tabella 2), per ciascuna delle quali sono state dateindicazioni adequate ai diversi stadi della vita del cane, utili a mettere inatto tutta unaserie di attività di prevenzione.
Tabella 2. Aree di assistenza sanitaria (AAS) |
|
|
|
|
|
|
|
|
|
|
Alcune di queste aree di assistenza sanitaria, come la prevenzione dei parassiti interni e la profilassi vaccinale, prevedono che le differenze di approccio tra i diversi stadi di vita siano per lo più quantitative. Essenzialmente, sono previsti un maggior numero di interventi nei cuccioli. In altre circostanze invece, lo stadio di vita可供a responsabilità ed interventi molto diversi,osi come è il caso della gestione comportamentale o della prevenzione dei rischi che si possono trovare nell’ambiente, casi quei che pongono in essere considerazioni ed attività differentiate, a seconda che si abbia a che fare con un cucciolo, un cane adulto o un cane anziano.
Una importante area di prevenzione considerata, è quella relativa alle zoonosi e alla sicurezza dell’uomo. La task de force sul tema suggerisce una series di comportamenti da adottare in clinica dai veterinari, e precauzioni da suggerire ai proprietari. Per le prime, si evidenzia l’importanza di informare sempre tutto il team della clinica, dell’arrivo di eventuali animali infetti e di limitarne le aree di accesso e gli spostamenti in struttura. Ai proprietari vanno dateindicazioniutili a limitarele occasions diicontatto dei propri animali con i selvatici, a rimuovere prontamente le feci, soprattutto dei cuccioli che possono diffondere grande quantità di uova di ascaridi zoonotici, e ad evitare l’alimentazione del cane con cibo crudo. Soprattutto, quest’ultima praticà è da sconsigliare per i cani impegnati nei programmi di pet therapy o nelle famiglie con soggetti immunocompromessi (ad esempio anziani, bambini con meno di 5 anni di età, donne in gravidanza o soggetti sottomosti a terapia immunosoppressiva).
Altrettanto importante l’attenzione dedicataagli aspetti comportamenti, che possono essere alla base di disagi con consequencese esitabili finanzihe nell’abbandono. è很重要的 che lo stato mentale del cane venga riportato nella sua cartella clinica,osi come che l’approccio al cane sia individualistico e non stereotipato. Altri aspetti,come I’importanza della socializzazione del cucciolo in età vaccinale, gli accorgimenti della fase di crescita più critica (tra i 6 mesi e i 3 anni di età) o di quelli relativi ai sintomi da disfunzioni cognitive dell’anziano,vengono trattati diffusamente in queste linee guida alle quali si rimanda per approfondimenti.
Un’area di assistenza agli molto rivalutata dal veterinario, è quella relatività alla valutazione degli aspetti nutrzionali. Gli Autori ricordano l’utilità di attribuire ai cani punteggi relativi alle condizioni corporea (body condition score, BCS) e muscolare (muscle condition score, MCS), punteggi che andrebbero inclusi nella cartella clinica del paziente. Inoltre, se nella fase di crescita è particolarmente importante considerare le peculiari necessità nutrzionali di但这a condizione fisologica, per l’adulto sare più importante controllare il peso, ad evitare i diffusi problemi di obesità che incidono negativamente sulla longevità del cane. Per finire, nei cani anziani si suggerisce di tenere sostro controllo il MCS che tende a diminuire,anche in misura della riduzione di movimento.
La salute riproduittiva del cane rappresents un’altra area di studio in continuo addivinenire,anche se a volte non è possibile dare chiari suggerimenti,per via di una
letteratura ancora carente di studi. Gli autori di queste linee guida, suggeriscono la castrazione/sterilizzazione di tutti i cani non destinati a riproduzione. L’intervento andrebbe eseguito entro i primi 6 mesi di età per i cani che da adulti peseranno meno di 20,5kg (prima del primo estro nelle cagne). Per i cani maschi che da adulti supereranno i 20,5kg, si suggerisce di intervenire tra i 9-15 mesi di età, per ridurre i rischi di problemi ortopedici o di alcuni tumori. Per le femme leindicazioni sono ancora molto chiare. Per i cani destinati a riproduzione, si affronteranno con l’allevatore tutte una series di tematiche che vanno dall’appropriata frequenza di riproduzione, alla consulenza genetica, nonché all’analisi dell’ appropriata età di riproduzione e ai periodici controlli di salute dell’apparato riproduittivo.
In conclusione di但这a sintesi, si voglioni considerare altre due aree in continua evoluzione in questi ultimi anni, e relative alle differenze di razza e al data base minimo per la valutazione individuale del trend di salute. Esistono agli diverse centinaia di razze canine e molte altre combinazioni di razze miste, ognuna con genetica e stili di vita diversi. Almeno due terzi di queste razze canine hanno uno o più disturbi genetici, per但这a ragione si impone un’attenzione particolare alle predispositionsi di razza,osi come a cogliere le similitudini dei cani di razza mista con quale di origine, per valutare l’eventualità di una predispositione a sviluppare gli stessi disturbi. Merita attenzioneanche la potenziale differenza dei range di normalità di molti test da una razza all’altra, un punto quello che ben si ricollega al successivo, il data base minimo individuale.
Una raccolta di dati minimi nelle varie fasi di vita del cane (Tabella 3), si è dimostrata utile a svelare malattie occulte, ed è di particolare utilità per “fotografia” il set point dei parametri del cane sano, per poi valutare nel tempo il trend di salute dell’animale. A proposito di quest’s ultimo, gli autori ricordano come alcune malattie vengano diagnosticate prima che i dati analitici diagnostici (per esempio di un analita di lavoratorio) superino il range normale dell’intervallo di riferimento di popolazione, grazie all’aumento osservato rispetto ai livelli precedenti dell’individual. Per chiarequesto punto, facciamo un esempio pratico: abbiamo un cane che per anni ha avuto una creatinina di 0,8 (con un intervallo di riferimento 0,7-1,3) e ad un successivo controlo la sua nuova concentrazione sierica di quello analita diventa 1,2. Ebbene questo non è un dato da trascurare, perchéanche se entro i limiti di riferimento per la specie,在哪auggliung in aureto, che delve
pertanto essere什么意思 molto accurata osservazione, in quanto potrebbeindicare una riduzione reale della funzione renale.
Tabella 3. Database minimo per stadio di vita dell'animale sano | ||||
| Cucciolo | Adulto giovane | Adulto maturò | Anziano |
Test fecale per parassiti | 4 nel primo anno | Da 1 a 4 l'anno, sulla base dello stile di vita e dei trattamenti antiparassitari | ||
Malattie da vettori | N/A | Annualmente | ||
Filaria | N/A | Annuallyntè; il test iniziale è importante per valutare lo stato precedente | Annualmente | |
Emogramma (HCT, RBC, WBC, leucogramma differenziale, stima piastrinica) | N/A | Considerare come linea di base iniziale | Annualmente | Ogni 6-12 mesi |
Biochimica: proteine tot., albumina, ALT, glucosio, BUN, Creatinina, [SDMA se disponibile] | N/A | Considerare il pannello minimo per iniziare | Minimo annuale (considerare un pannello completò) | Completo anni 6-12 mesi |
Analisi urine (peso specifico, sedimento, glucosio, chetoni, bilirubina, proteine, sangue occulto) | N/A | Iniziare | Annuale | Ogni 6-12 mesi |
Diagnostica per immagini | N/A | Si consideri lo screening radiografico ortopedico per cani di grande taglia | N/A | |
Ecociardografia |
| N/A | N/A | |
N/A: non applicabile, in quanto non c’è abbastanza letteratura per dare raccomandazioni, ma per alcune razze lo screening può essereindicato
In chiusura, si ricorda che l’obiettivo finale della prevenzione è migliorare la qualità della vita e la longevità del paziente. Diversi studi hanno rilevato che le ragioni di quello mancato obiettivo, sono spesso da ricercarsi in una inadeguata comunità del team clinico con i proprietari. Il suggerimento è di instaurare con quosti ultimi una comunità a due vie, avendo cura di non trascurare il ruolo centrale del proprietario nelle decisioni che riguardano i nostri pazienti. Il veterinario deve riuscire a trasmettere l’importanza della prevenzione sua nei termini deiosti, prevenire costa meno che curare, che dei risultati clinici, la diagnosi precoce aumenta le possibilità di successo della terapia.
Bartges et al., 2012. AAHA Canine Life Stage Guidelines. J Am Anim Hosp Assoc 48(1):1-11. doi: 10.5326/JAAHA-MS-4009
Creevy et al., 2019. 2019 AAHA Canine Life Stage Guidelines. J Am Anim Hosp Assoc 55(6):267-290. doi: 10.5326/JAAHA-MS-6999
Vogt et al., 2010. AAFP-AAHA: Feline Life Stage Guidelines. J Feline Med Surg 12(1):43-54. doi: 10.1016/j.jfms.2009.12.006.
Domenico Russo, DVM, PhD, Key Account Manager MYLAV La Vallonea Walter Bertazzolo, EBVS European Specialist in Veterinary Clinical Pathology (Dipl. ECVCP); Direttore Scientifico di MYLAV.
Nell’ultimo decennio l’American Animal Hospital Association e la American Association of Feline Practitioners hanno decidso di create delle linee guida per i medici veterinari, che li aiutassero ad individuire le procedure sanitarie più importanti da proporre ai proprietari di cani e gatti, al fine di salvaguardarne la salute di entrambi, focalizzando in particolare l’attenzione sull’ètà del paziente. Per agli fascia di età sono stati individui una series di punti critici su cui focalizzato gli interventi di prevenzione e cura dell’animale. Dop o aver trattato nel blog precedente le linee guida del cane, vediamo nei dettagli casa è stato proposto per gatto.

Queste linee guida, le prime nel loro genere, sono state redatte dall’American Animal Hospital Association e dall’American Association of Feline Practitioners con I’obiettivo di aiutare il veterinario a garantire un’assistenza sanitaria ottimale ai gatti. A tal fine e per tenere conto delle diverse esigenze del gatto, sono state identificcate 6 fasi di vita (tabella 1) e alcune principali aree di assistenza sanitaria (tabella 2). In quello modo, per ciascuna area specialistica si sono dettate leindicazioni e i suggerimenti adeguati ai vari stadi di vita.
Stadi di vita | Età del gatto | Equivalenza con l'età dell'uomo |
Gattino | 0-1 mese | 0-1 anni |
2-3 mesi | 2-4 anni | |
4 mesi | 6-8 anni | |
6 mesi | 10 anni | |
Giovane | 7 mesi | 12 anni |
12 mesi | 15 anni | |
18 mesi | 21 anni | |
2 anni | 24 anni | |
Adulto giovane (prime) | 3 anni | 28 anni |
4 anni | 32 anni | |
5 anni | 36 anni | |
6 anni | 40 anni | |
Adulto matures | 7 anni | 44 anni |
8 anni | 48 anni | |
9 anni | 52 anni | |
10 anni | 56 anni | |
Anziano | 11 anni | 60 anni |
12 anni | 64 anni | |
13 anni | 68 anni | |
14 anni | 72 anni | |
Geriatrico | 15 anni | 76 anni |
16 anni | 80 anni | |
20 anni | 84 anni |
Aree di assistenza sanitaria. | |
1 | Esame del benessere |
2 | Gestione del peso e nutrizzionale |
3 | Comportamento e ambiente |
4 | Parassiti |
5 | Vaccinazioni |
6 | Cure dentali |
Il punto di partenza è stato fissato nell’esame dello stato di salute del gatto. Non è stato nelle intenzioni degli Autori ribadire le basi della visita veterinaria, ma piuttosto di offrir une guida per assistere il veterinario. Il primo dato da sciogliere è stato quello relativivo alla necessità di trasmettere al proprietario l’importanza delle visite periodiche.
Il gatto è divertato negli USA il pet più popolare nelle case degli americani, tuttavia quello dato non fa il paio con le visite dal veterinario, dove il gatto viene portato molto meno di frequente rispetto al cane. Si ritiene che le principali ragioni di quello atteggiamento, siano identificabili nella dificoltà del proprietario a cogliere i segni di malattia del gatto e nella percezione di autosufficienza di quella specie, che contribuisce a rendere il proprietario meno incline a considerarne le esigenze. Inoltre, quando intervistati sull’argumento, i proprietari hanno risposto di non sapere che fosse necessario, che il veterinarian non lo aveva raccomandato, o che non gli erano stati ben spiegati la necessità e il beneficio. Altri proprietari hanno attribuito la causa delle mancate visite dal veterinario, allo stress del gatto.
Queste considerazioni fanno capire l’importanza di spiegare al proprietario che una diagnosi precoce di malattia o di disagi comportamenti, cui migliorare la gestione del problema e la qualità di vita dell’animale. Altrettanto importante, è far comprendere al proprietario che la vita del gatto ha un ritmo più veloce di quella dell’uomo (tabella 1), che proprio per questa ragione le condizioni di salute possonoambiare in tempi brevi, cui che spiega la necessità di visite almeno annuali e secondo molti esperti, meglio sarebbe se fosso semestrali. Il momento ottimale per affrontare questi temi cui sono essere quello della prima visita, quando il veterinario non dovrebbe perdere l’occasion di far comprendere ancH ivantaggi economici della prevenzione: prevenir costa meno che curare.
La task de force ha poi prodotto numerousi altri consigli, tra i quali l’utilità della raccolta periodica di un minimo di esami (tabella 3) che costituiranno la banca dati del soggetto. Questi dati sono utili per la diagnosi precoce di malattia e per seguire la tendenza di parametri clinici e di lavoratorio, il tutto finalizzato ad agevolare una diagnosi precoce, prima che i valori analitici dell’individualo superino quelli di riferimento della popolazione. Un argumento quest’s ultimo, che è stato ripreso da letteratura successiva alla pubblicazione di queste linee guida.
| Gattino/giovane | Adulto | Matouro | Anziano/geriatrico |
Emogramma Ematocrito, RBC, WBC, conta differenziale, citologia, piastrine | ± | ± | + | + |
Biochimica Almeno: TP, albumina, globuline, ALP, ALT, glucosio, BUN, creatinina, K+, P, Na+, Ca2+ | ± | ± | + | + |
Urine Peso specifico, sedimento, glucosio, chetoni, billirubina, proteine | ± | ± | + | + |
T4 |
| ± | ± | + |
Pressione sanguigna |
| ± | ± | + |
Test retrovirus | + | ± | ± | ± |
Esame feci | + | + | + | + |
La seconda area specialistica considerata è quella della nutrazione. Per dare le corre tte indicazioni sull’argomento è indispensable considerare lo stile e lo stadio di vita del gatto. I cuccioli, gli adulti con stile di vita indoor oppure quelli con stile di vita outdoor o i riproduitori, hanno esigenze nutrzionali diverse e per valutare l’adequatezza della dieta somministrata, si consigliano controlli periodici del peso e del punteggio delle condizioni corporee. Nelle linee guida si affrontanoanche argomenti molto dibattuti sull’alimentazione del gatto, come ad esempio la scelta tra le crochette e l’umido, oppure se nella scelta del cibo ci sia razionale nella letteratura a favore dei cibi a basso contentuto di carboidrati o di quelli grain free. Le conclusioni della task de force sono state che al momento della pubblicazione, non sussisteva no le evidenze scientifiche per consigliare un cibo piuttosto che un altro.
Molto importante è la cura degli aspetti comportamentali e dell’ambiente nel quale i gatti vivono. I gatti hanno bisogno di giusti stimoli e di un ambiente ricco. I gattini andrebbero abituati da subitoagli stimoli ambientali e ad essere manipolati, ricorrendoanche alrinforzo positivo.Fino alle 12 settimane di età prediligono le relazioni sociali con altri gatti,喙 le 12 settimane iniziano ad interessarsi di piùagli oggetti, ed in questa fase i glucattoli offrono l’opportunità di esercitare le normali sequenze predicatore. Bisognaspiegare ai proprietari l’importanza della pulizia del lalettiera,e suggerire di fornire ai gattini una scelta tra più tipi dilettieraosi che possano manifestare la loro preferenza.Quantoagli adulti eagli anziani,si tratta
di soggetti che tendono a ridurre le interazioni sociali e il gioco, la ridotta attività motoria, unitamente alla castrazione/sterilizzazione, cui lo comportare un aumento di peso che si sugerisce di contrastare stimolando sessioni quotidiani di gioco.
In queste linee guida vengonoanche fornite indicazioni di carattere generale sulla prevenzione dei parassiti e delle malattie infettive (vaccinazioni). Riguardo ai parassiti si ricorda di valutare lo stile di vita (indoor o outdoor, eventuali viaggi, prevalenza geografica delle parassitosi) e che un maggior numero di interventi contro i parassiti interni sono importanti nei gattini. Quindi si suggeriscono controlli fecali periodici (1-4 volte l’anno nei giovani, 1-2 volte l’anno dagli uomini in poi). Quanto alle vaccinazioni si ribadisce l’importanza di vaccinare tutti i gattini con i vaccini core e di valutare per i non core di volta in volta. In agli caso sia per i parassiti che per le vaccinazioni si rimanda alle rispettive linee guida per maggiori dettagli.
Per finire, l’ultima area specialistica considerata è quella delle cure dentali. Le malattie odontoiatriche sono molto diffuse e spesso i proprietari non ne hanno consapevolezza. Bisognerebbe spiegare ai proprietari che le cure odontoiatriche sono essentiali, per evitare patologie dolorose e che possono coinvolgere lo stato di benessere generale del gatto. Sarebbe una Buona pratica, ad esempio, abituare il gatto allo spazzolino dentale e spiegare che la cura dei denti riguarda il gatto in tutti gli stadi di vita.
Gli Autori conclusido ribadendo che è stato fatto il tentativo di fare sempre riferimento alle evidenze scientifiche, tuttavia esistono numerous lacune che dovanno essere colmate nei prossimi anni con ulteriori studi. Per cui quando è mancato il supporto di evidenze scientifiche pubblicate, si sono forniteindicazioni sulla base delle esperienze cliniche.
Vogt AH, Rodan I, Brown M, Brown S, Buffington CA Tony, Forman MJ Larue, Neilson J, Sparkes A. 2010. AAFP-AAHA: Feline Life Stage Guidelines. J Feline Med Surg 12(1):43-54. doi:10.1016/j.jfms.2009.12.006
Domenico Russo, DVM, PhD, Key Account Manager MYLAV La Vallonea
Walter Bertazzolo, EBVS European Specialist in Veterinary Clinical Pathology (Dipl. ECVCP); Direttore Scientifico di MYLAV.
Sembra un’osservazione logica e per molti cui poè apparire come un argomento ov-vio ed inutil. Ma vi assicuro che non lo è. Perché ci capita spesso di ricevere richieste di esami di approfondimento avanzati, su casi privi di una diagnostica di lavoratorio di base. Vi faccio alcuni esempi e vi spiego perché la casa può essere risultare alquanto rischiosa.
Il patologo deve sempre aver ben presente casa sta cercando e per quale ragione. Deve quando ave prima di tutto un visione del quadro generale e spesso è lui stesso a consigliare l’utilizzo di ulteriori colorazioni speciali, se lo ritiene necessario.
Alcune di queste indagini servono infatti per confirmare un sospetto diagnostico (per esempio la presenza di determinati microrganismi), ma quello sospetto deve essere supportato dai riliev di dell’esame citologico/istologico di base. Inoltre, alcune di queste colorazioni (es. l’mmunocitochimica per la differenziazione tra un linfoma B e un linfoma T), devono per forza essere precedute da una normale citologia: dobbiamo infatti essere certi prima di tutto che siamo realmente di fronte ad una neoplasia, poi possiamo procedere col tipizzarla.
Molti colleghi ad esempio, pensano che l’immunocitochimica serva per confermare il sospetto di linfoma: ciò non è sempre vero, sopratto quando la popolazione cellulare nel campione è ancora mista e non uniforme. L’immunocitochimica per linfoma ha come unico scopo la differenziazione della linea cellulare di origine (B-cell vs T-cell). Inoltre, perché una stadiazione clinica e la citologia edistologia di base, non vi permette nemmeno di gradare la neoplasia (indolente vs aggressiva).

Figura 1 - Esempio di colorazioni immunocitochimica per linfoma.
La PARR infatti non ha una specificità ed una sensibilità assolute, per cui il risultato della PCR deve essere interpretato nel contesto dei dati clinici e di quelli patologici di base. Un altro erre che viene talora commesso, è quello di richiedere la PARR per la determinazione del fenotipo della neoplasia linfoide. Questo strumento serve per supportare o meno il sospetto di una neoplasia linfoide, non per determinarne il fenotipo (per questo scopo ci sono altri metodi, come la citometria a flusso, l’immunocitochimica e l’immunoistochimica). Ci sono infatti neoplasie
linfoproliferative B-cell che risultano clonali per il recettore T, e viceversa, o addirittura linfomi B o T che riarrangiano clonalmente entrambi i recettori T e B.
Anche in quello caso, cui esempi e manca delle tipiche alterazioni di lavoratorioi di base, è abbastanza inutili ricorrere ai dosaggi del cortisolo pre e post-ACTH o dopo suppressione con desametazione. In caso di test positivo avremmo infatti una falsa conferma del loro (sbagliato) sospetto clinico: infatti multi animali con malattie concomitanti iper-producono cortisolo, alla in realtà ave una vera e propria sindrome di Cushing. Situazione simile si rileva nel caso della misurazione del solo T4: molti animali malati hanno un T4 basso, ma alla tipici segnici clinici e la caratteristica ipercolesterolemia, è alquanto improbabile che il vostro paziente sa realmente ipotiroideo.
Un animale con un quadro proteico perfettamente normale, difficoltà sare affetto da leishmaniosi. Un cane con una conta ed una stima piastrinica perfettamente normale, quasi sicuramente non potravere la piroplasmosi. Per cui in due situazioni come queste, andare a cercare quell’agente eziologico con tecniche avanzate come la PCR, risulterà quasi sicuramente inutile e dovremmo invece indirizzare la nostra attenzione e i nostri sforzi diagnostici in altre direzioni.
Walter Bertazzolo, EBVS European Specialist
in Veterinary Clinical Pathology (Dipl. ECVCP); Direttore Scientifico di MYLAV
Che ruolo hanno i virus nell’eziopatogenesi delle neoplasie del cane? Uno studio appena pubblicato da ricercatori italiani, ha cercato di rispondere a但这a domanda.
Nell’uomo, circa il
delle neoplasie sono associate ad infezioni virali, quali papillomavirus, virus di Epstein-Barr, virus dell’epatite B, virus di Kaposi, ecc.
In medicina veterinaria esistono diverse patologie virali con le medesime potenzialità (es. il papilloma virus del cane e il virus della leucemia felina del gatto, giusto per citarne un paio di interesse oncologico negli animali da compagnia).
Tuttavia, il ruolo di possibili infezioni virali di varia natura nella genesi dei tumori di diverso tipo, non è ancora stato indagato approfonditamente.

Figura 1 - Metastasi polmonari in un cane con emangiosarcoma.
Una recente review sistematica sull’argomento è stata pubblicata su Frontiers in Veterinary Science da due autori italiani, Diana Giannuzzi dell’Università di Padova e dal nostro consulente in patologia, il prof. Luca Aresu dell’Università di Torino.
Gli autori hanno selezionato tutti gli studi pubblicati in cui fosse stata applicata una Tecnologia chiamata “Next Generation Sequencing” su campioni di neoplasie canine, al fine di ricercare la presenza di genomi virali integrati nel DNA delle cellule neoplastiche.
Le neoplasie valutate includevano casi di linfoma, carcinoma transazionale della vescica, emangiosarcoma splenico, melanoma, ameloblastoma acantomatoso, osteosarcoma, glioma, neoplasie mammarie e mastocitoma, per un totale di 285 campioni.
In quello degli neoplasie gli autori non hanno identificato una associazione certa tra presenza di genoma virale e l’insorgenza della proliferazione tumorale.
Pertanto, il ruolo delle infezioni virali nell’eziopatogenesi di questo tipo di neoplasie canine è da considerarsi, allo stato attuale delle conoscenze, irrilevante.
Luca Aresu, Esperto MYLAV in patologia.
Walter Bertazzolo, EBVS European Specialist in Veterinary Clinical Pathology (Dipl. ECVCP); Direttore Scientifico di MYLAV
Questa è una domanda che mi assilla da anni e che mi fa discutere animosamente con gli amici clinici ed oncologi, agli volta che affrontiamo l’argumento.
Vista la diffusione e la frequenza con cui si esegue la diagnostica per immagini dell’addome nei nostri animali, è evidente a tutti quando sia un risconto Frequente, soprattutto per chi si occupa di ecografia. Non è una domanda a cui possiamo dare una risposta certa, ma cercHERò di analizzare la questione in maniera critica in quello post.
Nell’ultimo Trentennio, diversi lavori publicati su riviste internazionali, hanno cercato di rispondere alla questione in maniera oggettiva e scientifica. La maggior parte di questi studi indica che una buona maggioranza delle neoformazioni nodulari spleniche sono neoplastiche e maligne (neoplasie vascolari e mesenchimali di varia natura, ematopoietiche, metastasi, ecc.): tra QUESTe, l’emangiosarcoma (HSA) sembra farla nettamente da padrone.
Per gli oncologi esiste il dogma dei 2/3: ovvero i 2/3 circa delle neoformazioni spleniche sono neoplastiche e di queste, circa i 2/3 sono HSA.
Nella mia esperienza di “povero citologo” inceve mi trovo in una situazione complemente opposa: la stragrande maggioranza dei campioni citologici che analizzato in lavoratorio, sono riconducibili a processi di iperplasia linfoode ed ematopoesi extra-midollare splenica, del tutto benigni e spesso privi di significato clinico nel cane.
Nel nostro lavoratorio, analizziamo ormai circa un migliorio di campioni splenici all’anno mediante FNA: posso dire con certezza che il numero di HSA da me diagnosticati si può contare sulle dita di una mano nell’arco di 12 mesi! Come è possibile esta spiegare discrepanza?
Le pubblicazioni sull’argomento hanno purtroppo dei grossi “bias” (ovvero dei difetti nella progettazione dello studio, che ne indirizzano in un modo o nell’alto i

Figura 1 - Esempio di citologia da nodulo diiperplasia linfoide ed ematopoiesi extramidolare splenica. In questi campioni si rileva una commistione di cellule linfoidi (come in un linfonodo reattivo) e di precursors ematopoietici misti (come in un midollo osseo).
risultati): quosti inficiano pesantamente l’interpretazione di quando viene rilevato. Facciamo alcuni esempi di seguito.
Nel 2008 su JAVMA, Hammond et al. analizzano la prevalenza dell’HSA in 71 cani con massa splenica ed emoperitoneo; tutti questi pazienti hanno necessitato di una trasfusione. Ebbene di questi 71 casi, ben 54 avevano neoplasie maligne (di cui 50 HSA) e solo 17 lesioni benigne.
É lampante che in una simile popolazione di cani, sia molto più probabile rilevare una diagnosi finale di HSA rispetto alle altre neoplasie o noduli benigni, proprio perché esta neoplasia è più propensa a provocare un’emoaddome. Le lesioni
iperplastichebenigne solo occasionalmente vanno incontraduna rottura spontanea,per cui la loro prevalenza in un gruppo selezionato sulla base della presenza di un versamento emorragico addominale,risulta oviamente più bassa.

Figura 2 - Classico aspetto citologico di un HSA.
Nel 2016 Cleveland & Casale publicano uno studio su JAVMA in cui analizzano la tipologia di noduli splenici in cani splenectomizzati a seguito del risconto “accidentale” di tali lesions nella milza. In queste pazienti con noduli “non rotti” e quindi sulla emoperitoneo, ecco che il rapporto tra lesioni maligne e benigne si ribalta: su 105 campioni, 74 risultavano benigni nelle 31 maligni (e di questei circa 2/3 erano HSA, confermando la maggior frequenza di quello tipo di neoplasia tra i tumori splenici del cane).
Perché la situazione si è capovolta rispetto allo studio precedente? Semplicamente perché la selezione della popolazione canina nella studio è differente: i noduli sono integri, non c’é emoperitoneo e il rilievo è accidentale (per cui i pazienti sono又能 essere completamente asintomatici). In quello contesto è ovvio che la prevalenza delle lesioni benigne aumenta.
Altri studi, basati sempre su una diagnosi definitiva istologica, hanno molto prevalenze variabili tra lesions benigne e maligne: Eberle et al (Tieraztliche Praxis 2012) su 249 campioni rilevano
di lesions benigne e
maligne (con la consueta prevalenza di HSA, che rappresentava circa i 3/4 di queste neoplasie in但这a serie).
In uno storico studio del 1992 pubblicato da Spangler & Culbertson, su ben 1480 campioni istologici analizzati, la maggior parte delle lesions analizzate erano benigne (iperplasia, ematomi ed ematopoiesi extramidollare) nelle recente lavoro pubblicato da Davies & Taylor nel 2020 sul Vet Comp Oncol, su 230 casi, il
circa erano neoplasie maligne, di cui 2/3 come al solito veniva rappresentato dall’HSA. Anche i quello lavoro tuttavia, se si consideravano solo i campioni non associati ad emoaddome, le lesions benigne erano prevalenti (54% benigne VS 46% maligne).
In agli caso, tutti questi numeri tendono a non supportare la mia “impressione” di citologo: le diagnosi di neoplasia maligna nella mia casistica sono nettamente più rare rispetto a quella di malignità. Ho sempre pensato che但这a discrepanza possa essere spiegata col fatto che i noduli benigni vengono lasciati in sede e monitorati, per cui giungono all’esame istologico in prevalenza le neoplasie maligne, e questo ne spieghi la sovra-rappresentazione negli studi pubblicati, che si basano quasi esclusivamente su una diagnosi finale di tipo istologico.
Questa mia impressione è stata finalmente supportata da un recente studio pubblicato da Yankin et al su J Vet Intern Med (2020): in quello articolo gli autori hanno selezionato 125 casi di citologie da milze con alterazioni ecografiche del parenchima o con noduli splenici
cm. Di questti 125 casi, solo 22 erano neoplastici ed in prevalenza linfomi (10 casi) e solo 1 HSA! La stragrande maggioranza dei campioni era quando da ricondurre ad alterazioni non neoplastiche, di cui 100 considerate clinicamente irrilevanti.
É ovvio cheanche in quest’ultimo lavoro ci sono bias importanti:per esempio ave- re escluso le lesions di dimensioni
cm potrebber aver fatto sottostimare alcune forme neoplastiche rispetto ad autre. Inoltre, non avendo una conferma istologica, è altrettanto possibile che alcune lesions apparentemente benigne all’esame cito- logico nascondano una neoplasia (per esempio un’iperplasia linfoide diagnostica
ta in citologia, potrebbe rivelarsi>Ince un linfoma con crescita nodulare all’esame istologico, oppure una ematopoiesi extra-midollare nascondere un HSA).

Figura 3 - Esame istologico di un nodulo splenico, in cui prevalvano gli aspetti di iperplasia linfoode (LH) ed ematopoiesi extra-midollare (EMH), ma in un’area limitrofa era presenta una proliferazione angiosarcomatasa (nell’angolo in basso a sinistra si intravede una porzione periferica della neoplasia, HSA).
Non credo di aver dato una risposta definitiva alla domanda iniziale, in quanto altri studi con casistiche molto più estese, saranno necessari per averere più chiara la situazione. Ma almeno abbiamo incominciato a mettere in discussione la regola dei 2/3 tanto amata dagli oncologi.
Non solo: una volta che saranno meglio chiarite le reali prevalenze delle patologie spleniche nodulari del cane, sare è possibile averre delle linee guida condivise su come gestirle clinicamente (monitorarle VS intervenire chirurgicamente ad esempio).
Walter Bertazzolo, EBVS European Specialist in Veterinary Clinical Pathology (Dipl. ECVCP); Direttore Scientifico di MYLAV.
Recentamente il Journal of Feline Medicine and Surgery has pubblicato un aggiornamento sulle retrovirosi feline, con le relative guidelines per la gestione clinica (Little et al, Journal of Feline Medicine and Surgery 2020; 22: 5-30). Queste nuove linee guida rappresentano leindicazioni più aggiornate della AAFP:cercherò di riassumervi in quello post i dati più salienti e le novità rispetto al passato.
Si stima che la prevalenza delle infezioni retrovirali si attesti intorno al
sua per FIV che per FeLV in alcuni studi europei e nord-americiani, nelle appare più elevata in studi condotti in Australia, Asia, sud Europa e sud America/Caraibi (fino al
). Queste virosi sono quindi sempre di estrema attualiità per i clinici che si occupano di medicina felina.
Infezione (via oronasale++)+; verticale, morsi, accoppiamento)

RNA virale rilevabile a 7 gg circa

DNA provirale rilevabile a 15 gg circa

Figura 1 - Schema della patogenesi dell’infezione da FeLV.
Antigene virale rilevabile a 30 gg circa
In relazione all’infezione da FeLV, le attuali linee guida distinguono queste tre categorie di soggetti che vengono in contato con il virus (come da Figura 1):
midollo o secreti. Questi pazienti hanno quando eliminato l’infezione oppure la quantità di virus presente è irrilevabile con le attuali metodiche di rilevazione.
A parte il discorso relativo alle diverse terminologie utilizzate, emerge un dato interessante: una volta infettato dal virus FeLV, l’esito dell’infezione cui èssere differente (vedere Figura 2).
In passato si supponeva che tra i gatti infettati, esistesse una simile proportione tra soggetti con infezione abortiva, regressiva e progressiva. Gli studi più recenti molto inceve che i gatti con infezioni abortive sarebbbero molto più rappresentati, ad eccezione di quale condizioni in cui esiste una forte pressione da parte dell’agente virale (es. gruppi di gatti infetti e non, che convivono strettamente e continuamente, come nelle colonie).
Da questo dato ne derives che un singolo test positivo (antigenico o molecolare), sopratto se in un soggetto giovane, non deve necessariamente essere considerato come indicatori di una malattia consolidata, in quanto molti gatti riescono ad eliminare l’infezione o a mantenerla molto controlo.
Test multipli e ripetuti nel tempo possono quando essere consigliabili in alcuni pa-zienti, o in caso di risultati contrastanti o dubbi.

Ig: Immunoglobuline/Anticorpi
Figura 2 - Esempio schematico degli scenari consequenti all’infezione con FeLV.
In relazione alle modalità di trasmissione delle due virosi, si sottolinea l’importanza e la preponderanza della via orale/salivare (es. condivisione di ciotole per cibo ed acqua) per il FeLV e di quella mediating morsi/combattimenti per il FIV (Figure 1 e 3).

Figura 3 - Schema della patogenesi dell’infezione con FIV.
Data l’importanza dell’individuzione e della separazione dei gatti infetti da quelli esenti, le nuove linee guida pongono molta attenzione sull’utilizzo dei test diagnostici. In realtà non ci sono grandi novità rispetto a quanto gli pubblicato sui nostri precedenti blog sull’argomento, a cui vi rimandiamo per i consigli pratici:
https://www.mylavblog.net/generica/148-148.html
https://www.mylavblog.net/generica/126-126.html
Si sottolinea sempre di tener conta dei tempi di incubazione delle due infezioni, in modo da evitare possibili falsi negativi,或者其他 che di considerare l’interferenza degli anticorpi materni per quanto riguarda l’esame sierologico per FIV (possibili falsi positivi fino a 6 mesi di età). Per valutare questi potenziali falsi positivi alla FIV, il test andrebbe quindi ripetuto dopo i 6 mesi di età, oppure andrebbe effettuata direttamente una PCR di conferma (che rilevando direttamente il genoma virale, non risente degli anticorpi passivi di derivazione domesterna).
Nei paesi in cui è disponibile la vaccinazione per la FIV, si deve considerare il possibile effetto della risposta vaccinale sul risultato del test anticorpale per FIV: nelle alcuni kit rapidi non subiscono l’interferenza degli anticorpi vaccinali, altri esitano in risultati falsamente positivi (se effettuati entro 6 mesi dal vaccino), per cui è importante in questei pazienti, conoscere lo stato vaccinale e la specificità del kit utilizzato. Questa interferenza non sussiste invece per l’eventuale vaccinazione contro FeLV: i test rapidi individiano gli antigeni virali specifici e non la risposta anticorpale del gatto e non danno cross-reazione con gli antigeni usati nei vaccini. Ovviamente le vaccinazioni non hanno alcun effetto interferente sui test molecolari mediate PCR, sia per FIV che per FeLV.
Molta enfasiiene riservata sulle misure preventive; innanzi tutto vengono identificati fattori, ben conosciuti, che favoriscono la diffusione delle due retrovirosi tra le popolazioni di felini, quali ad esempio: sesso maschile, tendenza all’aggressività e ai combattimenti, accesso all’esterno e contatto con gatti infetti, fatto sessuale, trasmissione da madre infetta (quest’sultima più importante per FeLV che per FIV). Si sottolinea pertanto l’importanza dell’individuzione e della segregazione dei soggetti infetti, o dallo stato retrovirale sconosciuto, da quelli sani sicuramente negativi.
La vaccinazione contro FeLV ha dimostrato efficacia nella protezione contro l’infezione (riduzione del rischio di infettarsi mediante il contatto con gatti FeLV-positivi) maanche nel ridurre la probabilità di un’evoluzione verso la malattia progressiva. Si sconsiglia invece l’utilizzo della vaccinazione FeLV in gatti più infetti, in quanto inutile (oltre che potenzialmente rischiosa per altri effetti avversi al vaccino).
Tutti i gatti e gli adulti a rischio di infezione, andrebbero quindi testati e, se negativi, vaccinati contro la FeLV. La prima vaccinazione andrebbe effettuata a partire dall’
settimana di età, con un richiamo dopo 20-30 giorni e successivement con ulteriori richiami annuali oppure agli 2-3 anni in base a rischio di contagio e al tipo di vaccino usato. Di seguito uno schema riassuntivo di quando dettato delle linee guida.
La vaccinazione contro la FIV”Ince ha lostrato risultati più questionabili: il vaccino per FIV è disponibile solo in alcuni paesi ed è comunque considerato “non-core”. Inoltre si deve ricordare il possibile effetto interferente nei confronti dei test sierologici nei gatti vaccinati per FIV.
L’infezione con quosti retrovirus non significa necessariamente una riduzione marcata dell’aspettativa di vita, in particolare per quella con FIV.
I gatti FIV e/o FeLV positivi sono andare incontrato a numerous condizioni patologiche che vengono favorite dall’infezione virale persistente: infezioni opportuniste di varia natura, infestazioni micotiche, neoplasie, patologie immuno-mediate, ecc. Pertanto questi pazienti andrebbero individui e mantenuti in condizioni tali da ridurre il rischio di trasmissione della retrovirosi ad altri gatti, maanche di ridurre il rischio di contrarre patologie favorite dallo stato di immuno-depressione (es. una micoplasmosi trasmessa dal morso di pulci mediante il controllo periodico degli ectoparassiti).
Questi pazienti andrebbero sterilizzati,或者其他 che rivalutati clinicamente e mediate un check-up di lavoratorioi agli 6 mesi.
Quando si valutano pazienti malati e positivi a una infezione retrovirale, bisogna sempreDemandarsi se i sintomi e le alterazioni clinico-patologiche osservate, possano essere più o meno correlibili con l’infezione (vedi tabella 1), per evitare errorsi diagnostici e di gestione clinica.
Tabella 1 - Definire le cause dei segni clinici in gatti infetti da retrovirus
Non correlibili a FIV/FeLV | Potenzialmente secondarie a FIV/FeLV | Direttamente correlibili a FIV/FeLV |
Patologie feline chiaramente non legate a una infezione retrovirale (es. Una patologia endocrina, una malattia renale, ecc.) | Patologie feline che possono essere facilitate da una immuno-deficienza indotta dal retrovirus (es. Infezioni, gengivo-stomatiti, neoplasie ematopoietiche, ecc.) | Patologie direttamente causate dal retrovirus: FeLV: citopenie da patologia midollare, linfomi/leucemie, patologie neurollogiche FIV: immuno-suppressione, patologie neurollogiche |
L’utilizzo di farmaci antivirali (come la zidovudina) o dell’interferone è stato proposto in gatti retrovirus-positivi e con patologie correlibili all’infezione. Tuttavia le evidenze scientifiche sulla reale utilità di queste terapiè è questionabile.
Per coloro che fosso interessati ad approbondire l’argumento, vi invito a leggere l’articolo originale.
Walter Bertazzolo, EBVS European Specialist in Veterinary Clinical Pathology (Dipl. ECVCP); Direttore Scientifico di MYLAV
Molti radiologi ancora sottovalutano quando deleterio possa essere il gel utilizzato per le indagini ecografiche, sui campioni citologici ottenuti per via eco-guidata.
Se non volete ottenere campioni citologici inutili, ecco quale consiglio pratico.

Figura 3 - Prelievo per FNA eco-guidato. Foto per gentile concessione di Federica Rossi, EBVS European Specialist in Veterinary Diagnostic Investigation (Dipl. ECVDI).
Quando eseguite campioni per agoaspirazione eco-guidati, se state utilizzando gel ecografico in abbondanza, è molto probabile che parte di quello materiale finisca per mescolarsi con il materiale raccolto nell’ago.
Quando deponete il vostro campione sul vetrino per strisciarlo, il gel verrà strisciato con le cellule campionate nell’ago. Vi sembrera的概率mente di aver ottenuto un ottimo campione, perché il gel assomiglia macroscopicamente a quei prelievi di ottima cellularità,anche dopo colorazione (Figura 2).

Figura 2 - Striscio con abbondante materiale viola colorato (gel ecografico).
L’effetto che ne otterrete all’esame citologico è molto nella figura successiva (Figura 3): abbondante materiale fusicia particolato ed eterogeneo, che copre qualsiasi casa.
In un prelimievo così, è impossibile poter effettuire una valutazione microscopica, il campione risulterà pertanto non diagnostico e quando inutile.

Figura 3 - Aspetto microscopico del gel ecografico dopo la colorazione con le normali metodiche citologiche.
Bisogna eliminare per bene il gel alla cute prima di effettuare i prelimievi per ago-a-spirazione. Una volta che avete terminato le vostre valutazioni morfologiche ed eventuali misurazioni, asportate tutto il gel; poi utilizzate un altro mezzo liquido per ottimizzare il contatto tra sonda ecografica e cute, per ottenere una guida ecografica alla biopsia citologica.
L’ideale è del banale alcool, ma se avete il timore di poter danneggiare la sonda,anche della fisiologica più andare bene.
Walter Bertazzolo, EBVS European Specialist in Veterinary Clinical Pathology (Dipl. ECVCP); Direttore Scientifico di MYLAV.
Perché gli oncologi richiedono ormai routinariamente la biopsia linfonodale in un caso di sospetto linfoma? La sola citologia non è sufficiente per una diagnosi definitiva di neoplasia? Cosa può aggiriungere di più un istologico? Cerchiamo di fare un po’ di chiarezza in quello post.
Quando ci si approccaia ad un paziente con linfadenomegalia generalizzata e con sospetta neoplasia info-proliferativa,或者其他 gli esami di base (ematobiochimica, elettrforesi, esame urine ed eventuali sierologia in caso di sospette malattie infettive) è assolutamente necessario ricorrere ad una citologia per agoaspirazione dei linfonodi colpiti.
In una Buona percentuale di casi (soprattutto nei cani, in cui predominano i linfomi B diffusi e a grande cellule), l’esame citologico è sufficiente per emettere una diagnosi di linfoma o comunque di neoplasia ematopoietica.
Se questo approccio era considerato sufficiente negli anni ’80 e ’90 per instaurare una terapia, con il crescere delle conoscenze, ci si è resiconto che molte altre informazioni sono necessarie per definire meglio quale neoplasia ematopoietica stiamo affrontando e quando quale possa essere la terapia migliorare,或者其他 poter emettere una prognosi. In quello contesto la fenotipizzazione e la stadiazione clinica completa assumono un ruolo fondamentale.
Ma perché allora molti oncologi suggeriscono comunque di effettuare una biopsia linfonodale escissionale per definire più recenta meglio la patologia neoplastica? I motivi sono molteplici e cercheremo di riassumerli con una series di esempi di seguito.
Bisogna innanzitutto sottolineare che quando si esegue una biopsia linfonodale, è molto importante evitare biopsie tru-cut o incisionali/cuneiformi, in quanto in caso di una proliferazione neoplastica non diffusa (es. un linfomafollicolare o della zona T), c’è il rischio che il patologo abbia grosse dificoltà ad interpretare il quadro ed
a distinguere una patologia reattiva da una neoplasistica. In secondo luogo, in caso di una forma diffusa che interessi un po’ tutti i linfonodi esplorabili, è consigliabile asportare sicuramente un linfonodo più accessibile (es. un popliteo) ed evitare possibilmente i mandibolari (a meno che siano gli unici coinvolti), più facilemente affetti da forme di graveiperplasia (per la vicinanza con il cavo orale), che possocono mettere in dificoltà il patologo in un diagnostico differenziale tra neoplasia e forma reattiva.

Figura 1 - Imagine intra-operatorio di linfadenctomia mandibolare, per gentile concessione del Prof. Paolo Buracco, EBVS European Specialist in Veterinary Surgery (Dipl. ECVS).
Vediamo alcuni scenari in cui la biopsia escissionale di un linfonodo può rivelarsi risolutiva o comunque molto utile:
Scenario 1 – Un linfoma B a grande cellule in cui il tessuto linfonodale normale non è ancora stato Completely sostituito alla popolazione neoplastica. In quello
caso la citologia può essere difficoltà nel distinguere una graveiperplasiafollicolare da una neoplasia. Basta una simplice variazione nel posizionamento dell’ago, che potremmo campionare un excesso di cellule voluminose o di più piccole. In casi dubbi è pertanto sempre raccomandabile una conferma con istologia. Quest’ultima ha la possibilità di valutare l’architettura globale del linfonodo che, se sover-tita, èindicativa di una neoplasia.
Scenario 2 – Un linfoma T-zone (“small clear”, “hand-mirror” o come preferite chiamarlo in citologia…) VS unaiperplasia della paracorticale. Ci sono casi di iperplasia della zona T/paracorticale che citologicamente possono lavoramente mimare un linfoma indolente di quello tipo. L’istologia vi cui dare una risposta certa nella maggior parte dei casi.
Scenario 3 – Un linfomafollicolare:questi rari linfomi sono praticamente impossibilidadiagnosticareincitologia:vedreste un quadro misto,sovrapponibileaquello diunaiperplasiafollicolare.Per cui se lacitologia vi emette una diagnosi di forma reattiva ma la linfadenomegalia persiste o peggiora,l’istologico è sicura-mente la scelta dafare.
Scenario 4 – I linfomi del gatto…il terrore dei citologi: molti linfomi felini sono veramente difficili da diagnosticare con certezza mediante citologia. Ad esempio il ciò detto “Hodgkin-like” (ché poi sarebbe un linfoma B a granidi cellule con un infiltrato misto di linfociti T, istiociti e granulociti), cui venir sospettato da un occhio citologico esperto, ma deve essere confirmato alla biopsia istologica.
Scenario 5 – I linfomi della zona marginale (cosi detti “macro-nucleolated medium sized cells” in citologia): ancche quosti possono lavoramente essere confusi con unaiperplasia della stessa zona marginale in citologia.
Senza un istologico di conferma non si possono diagnosticare con facilità. Inoltré la fenotipizzazione con citofluorimetria da sola, in questi casi vi direbbe che si tratta di un linfoma B: ma quello non è un linfoma B ad alto grado, come il classico DLBCL (Diffuse Large B Cell Lymphoma) del cane,bensù una neoplasia indolente.
Senza l’istologia di conferma definitiva, potremmo fare degli errorsi di gestione non solo da un punto di vista terapeutico, maanche di inquadramento prognostico. Ad esempio,mente per il linfoma DLBCL un’infiltrazione del midollo
si accompagna ad una prognosi sfavorevole, per il linfoma della zona marginale, tale cut-off èosto al
. Senza diagnosi istopatologica e alla percentuale di infiltrazione midollare citometrica, è impossibile dare informazioni prognostiche al proprietario.

Figura 2 - Esempio di aspetto istologico ed immuno-istochimico (a destra, mediante colorazione anti-CD20) di linfoma B a grandi cellule (DLBCL) del cane. Per gentile concessione di Silvia Benali, EBVS European Specialist in Veterinary Pathology (DiplECVP).
In conclusione, sebbene i protocolli terapeutici personalizzati siano ancora nella loro fase embrionale, il comportamento biologico dei diversi istotipi inizia ad essere svelato. In linea con l’oncologia umana, assisteremo presto a protocolli terapeutici personalizzati, che non terranno conto soltanto dello stadio clinico e del fenotipo, maanche dell’istotipo e verosimilmente delle caratteristiche molecolari dei diversi linfomi.
Laura Marconato, EBVS European Specialist in Veterinary Small Animal Oncology (Dipl. ECVIM-Oncology), Esperto MYLAV.
Walter Bertazzolo, EBVS European Specialist in Veterinary Clinical Pathology (Dipl. ECVCP); Direttore Scientifico di MYLAV.
La poliartrite immuno-mediata è una patologia tanto comune quanto sotto-diagnosticata e sottovalutata nella pratica. Il problema principale è che la maggior parte dei clinici si immagina che esta patologia determini sempre gravi alterazioni morfologiche e funzionali articolari.
Non è casi: molti cani e gatti con poliartrite immuno-mediatedi hanno come unici segni clinici l’ipertermia e l’abbattimento.
Il primo step è quindi sospettarla sempre in questi casi e poi procedere con gli accertamenti indicati per una diagnosi definitiva. Con questo blog, cerchiamo di darvi alcuni consigli pratici per raggiungere quello obiettivo.
La poliartrite è per definizione una flogosi, che interessa due o più articolazioni: ma casa intendiamo nella specifico quando parliamo di poliartriti immuno-mediate? Si tratta di una malattia poli-articolare (o miglior un gruppo di malattie) di tipo inflammatorio, nella cui patogenesi gioca un ruolo fondamentale ilsystema immunitario.
È infatti comunmente accettato che un meccanismo di ipersensibilità di tipo III porti alla formazione di immuno-compressi circolanti e successivement ad un loro deposito a livello articolare, causando un’attivazione a Cascata del complemento che scatena la risposta inflammatoria. Quest’ultima esita nel richiamo di numerousi granulociti neutrofili (oltre a più rari linfociti e macrofagi) nella membrana sinoviale e quindi nel liquido sinoviale. In alcuni casi più rari, la risposta è invece cellulo-mediata (ipersensibilità di IV tipo) ed è quindi mediata principamente da linfociti.
Le cause che possono portare a questa attivazione delsystema immunitario sono estremamente varie, e permettono di classificare le poliarriti immuno-miate in:

Figura 1 - Schema riassuntivo delle potenziali cause di poliartrite nel cane e nel gatto.
Partendo dal presupposto che si tratta di malattie molto frequenti, in particolare nel cane, quando dobbiamo sospettarle e quindi indagarle? Il segnalamento tipico è quello di un paziente giovane/adulto, con segni clinici aspecifici e tipicamente intermittenti quali:
Rigidity
- Difficilità ad alzarsi
Zoppia
Articolazioni tumefatte, calde e dolenti
- Letargia
Depressione
- Anoressia
- Linfoadenomegalia
- Pu/Pd
- Febbre (secondo alcuni autori le poliarriti immuno-mediate sono la causa di almeno il
delle febbri di origine sconosciuta nel cane!)
- Eventuali segni riferibili alla malattia primaria (in caso di forme reattive)
É importante ricordare che non tutti questi segni clinici siano sempre presenti, anzi!
Contrariamente a quanto si può pensare, per esempio, i cani con poliartrite spesso non zoppicano e non presentano gonfiore delle articolazioni.
Anche quest’ultimo segno, quando presente, non coinvolge necessariamente tutte le articolazioni; sembrano infatti essere maggiornente colpite quale distali (carpo, tarso, interdigitali, ginocchio e gomito), ma è possibleanche un coinvolgimento ad esempio solo del gomito o del rachide come unico segno.
La febbre è il segno cardine! Ogni cane o gatto con FUO (Fever of Unknown Origin) andrebbe indagato per una possibile poliartrite.
In alcuni casi la poliartrite immuno-mediatedi si insertisce in un contesto inflammatorio più vasto, in cui si associanoENTERITE e dolorabilita muscolare più o meno diffusa.
La diagnosi definitiva di una poliartrite immuno-mediata,或者其他 sul sospetto clinico, si basa sull’esame citologico del liquido sinoviale, prelevatotramite artrocentesi da almeno 4 diverse articolazioni a prescindere dai segni clinici. L’alterazione che si riscontra è una flogosi neutrofilica non settica che cui assere accompaniesnata da altri reperti macroscopici (aumento della torbidità, diminuzione della viscosità) e microscopici (aumento dei sinoviociti, cellule LE in corso di SLE, aumento e prevalenza di linfociti in alcune più rare forme).
É importante effettuare esta procedura diagnostica in pazienti NON in terapia con farmaci anti-inflammatori (in particolare corticosteroidi), per evitare possibili falsi negativi.
A dato si deve aggungere l’esame batteriologico del liquido sinoviale, utile per escludere forme batteriche, più rare e che difficultmente colpiscono più di una articolazione.
Per l’esame batteriologico del liquido sinoviale vi invitiamo a consultare quello,.
nosto blog passato: https://www.mylavblog.net/microbiologia/240-240.html

Video: esempio di artrocentesi in cane con artrosinovite suppurativa. Si noti l’abbondanza del fluido raccolta, la ridotta viscosità e l’aspetto emorragico e turbido, tutte caratteristiche macroscopiche patologiche.

Figura 2 - Esame citologico a basso ingrandimento di liquido sinoviale di cane con flogosi neutrofilica/suppurativa. In un liquido sinoviale normale, a questo ingrandimento, si osserverbbe solo pochi sinoviociti ed i neutrofili rappresenterebbbero meno del
delle cellule nucleate totali. In quello campione inceve i neutrofili,anche se coartati e non sempre ben riconoscibili, sono molto numerosi e rappresentano la quasi totalità delle cellule nucleate.
Il protocollo diagnostico preveo inoltre:
Tabella 1 - Elenco delle procedure diagnostiche utili in caso di poliartrite e possibili risultati.
PROCEDURA DIAGNOSTICA | RISULTATO |
Analisi del liquido sinoviale | >torbidità e < viscositàEssudato fibrinosoNeutrofili non degeneratiAumento dei sinoviocitiCellule LE (SLE) (evento molto raro)Aumento linfociti |
Esame emocromocitometrico | Anemia (AID)LeucocitosiTrombocitopenia |
Profilo chimico | IpoalbuminemiaAumento CRP |
Urine | Proteinuria |
Ana test | Positivo se SLE |
Radiografie degli arti | Effusione intra-articolare, tumefazione tessuti molli peri-articolari, erosione in alcuni casi |
Istologia della sinovia | Infiltrazione di granulociti e mononucleati |
Nel gatto le poliarriti sembrano essere decidamente più rare che nel cane; esiste tutavia la possibilità che l’incidenza di但这a patologia venga sottostimata. I felini infatti nascondono bene il dolore, e non è insolito che le uniche manifestazioni di poliartrite siano febbre e/o riluttanza al movimento, rendendo ancora più dificile la diagnosi.
Al contrario del cane, inoltre, le forme infettive sono più frequenti di quella immuno-mediate, pertanto è sempre consigliato eseguire l’esame batteriologico del liquido sinoviale.
Infine, più essere utile ricordare l’associazione Calicivirus-poliartrite, possibile sua in corso di infezioni acute, sua come complicazione (transitoria ed autolimitante) della vaccinazione.
Per conclusione vi mostriamo un algoitmo diagnostico amplificato e riassuntivo, degli step necessari per la diagnosi di poliartrite immuno-mediata. Nella prossima puntata vi daremo dei consigli per la gestione terapeutica di queste patologie.
Sospetto clinico di poliartrite:
febbre persistente/intermittente (da modesta a molto elevata)
rigidità/dolore articolare
tumefazioni articolari, zoppie
![]()
Centesi articolari (se possibile campionare carpi, tarsi, gomiti, ginocchia e spalle)
![]()
Diagnosi confirmata se flogosi in almeno due prelievi e se batteriologico sinoviale negativo
![]()
Francesco Dondi, Università di Bologna e Esperto MYLAV per la medicina interna
Walter Bertazzolo, EBVS European Specialist in Veterinary
Clinical Pathology (Dipl. ECVCP); Direttore Scientifico di MYLAV
Dopo avervi indicate gli step necessari per un corretto inquadramento diagnostico delle poliartriti immuno-mediate, vi diam do anni alcuni consiglio pratici sulla gestione terapeutica e sul monitoraggio clinico di queste patologie complesse.
Il trattamento delle poliarriti immuno-mediate precede da un lato di ridurre dolore ed infiammazione e dall’alto di trattare le eventuali malattie sottostanti (se presenti e se si è riusciti a identificare un “trigger” scatenante).
A tal proposito, nelle zone in cui sono comuni le malattie trasmesse da zecche, non è scorretto impostare una terapia di tipo empirico con Doxiciclina a 10 mg/Kg PO SID o BID per 28 giorni, eventualmente in assocazione ad analgesici quali FANS, tramadolo, oppioidi o altre a seconda del paziente che abbiamo di fronte (es.: nefropatico o meno). Nei cani in cui esta scelta risulta efficace, il miglioramento clinico avviene più nei primi 7 giorni e non necessita di immuno-suppressione.
Per le forme primarie idiopatiche,quelle causate da possibili trattamenti terapeutici/vaccinali e patologie che non si riescono a controllare/eliminare completamente (es. neoplasie) e quella comunique persistenti independentemente dal “trigger” scatenante, sare invence necessario ricorrere ad una terapia immunosoppressiva, ed è importante intraprenderla solo dopo aver ragionevolmente escluso una poliartrite infettiva, mediante esami microbiologici del liquido sinoviale e/o della membrana sinoviale.
I farmaci di prima linea per il trattamento delle poliarriti immuno-miate sono i corticosteroidi (short term o long term), utilizzati a dosaggio immunosoppressivo, per indurre la remissione clinica e successivement con dosaggio a scalare fino al raggiungimento della dose minima necessaria per Maintainere la sintomatologia in remissione. Il trattamento deve avere una durata minima di 4 anni, o anticor meglio, fino alla remissione completa della sintomatologia clinica, secondo lo schema in Figura 1.

Figura 1 - Schema di trattamento immuno-suppressivo con cortisonici a scalare.
Si possono utilizzare ad esempio prednisone o prednisolone a 1-2 mg/kg PO BID, rivolutando il paziente dopo i primi 10-14 giorni e poi con cadenza mensile andando a ridurre (del 25 - 50%) il dosaggio di volta inolta, a fronte di un miglioramento clinico.
In caso di mancata risposta o recidiva, sarebbe necessario augmentare la dose di corticosteroidi o associare un immunosoppressore di seconda linea come ad esempio il micofenolato mofetile (MMF) 5-10 mg/kg PO BID, con l’obiettivo di scalare la dose di corticosteroidi del
agli 2 settimane fino a sospenderli, e mantenerere invariata那一 della MMF per i primi 2 mesi. Dopo quello periodo, se il paziente risultata in remissione clinica, si potrà dimezzare il dosaggio del MMF per ulteriori 2 mesi per poi sospenderlo (Figura 2).

Figura 2 - Schema di combinazione di cortisonici e MMF.
Esempio assocazione
Nel gatto è consigliato utilizzato和其他 corticosteroidi rispetto al prednisone, come prednisolone, metil-prednisolone ecc., eventualmente in associazione al cloram-bucile 4 mg/gatto da ripetere anni 3 settimane o metà dose anni 2/3 giorni.
Anche altri immunosoppressori (vedi Tabella 1) vengono riportati in letteratura come possibili alternative/associazioni ai corticosteroidi nel trattamento di但这a patologia, tuttavia gli studi a riguardo ad agli non sono molti e non è possible stabilire se alcuni siano meglio di altri; l’efficacia sembra infatti variare molto nei singoli casi. Molti casi rispondono bene al solo utilizzato di corticosteroidi, quando i casi più complessi o recidivanti richiedono una terapia combinata.
Tabella 1 - Opzioni terapeutiche per la terapia immuno-suppressiva delle poliartriti immuno-mediate.
FARMACO | DOSE INIZIALE | EFFETTI COLLATERALI | COSTO prezzo/giorno per un cane di 20 kg: |
Prednisone Prednisolone | 2-4mg/kg/die | pu/pd, polifagia, tachipnea, proteinuria, sintomi GI, dermatopatia … | 1,5 € |
Micofenolato Mofetile | 10-20 mg/kg/die | vomito, diarea, anoressia, dimagrimento, ↑ rischio infezione, neutropenia (mielosoppressione) | 1 € |
Leflunomide | 2-4 mg/kg/die (per 1-6 settimane) | riduzione dell'appietito, vomito, letargia, linfopenia, anemia (mielosoppressione) | 20 € |
Ciclosporine | 10 mg/kg/die | vomito, diarea, anoressia e nausea, iperplasia gengivale e ipetricosi, ↑ rischio infezioni, lesioni cutanee | 13 € |
Azatioprine | 2 mg/kg/die (per 3-4 sett, poi a giorni alternì) | vomito, diarea, anoressia, epatopatia, pancreopatia, mielosoppressione | 0.6 € |
Ciclofosfamide | 1,5-2,5 mg/Kg (4 giorni su 7) | mielosoppressione, cistite emorragica, sintomi GI, alopecia | 0.4 € |
Per quanto riguarda il monitoraggio di questi pazienti, un primo controllo a distanza di circa 7 giorni dall’introduzione della terapia immunosoppressiva è utile per aggiestare la dose o associare un secondo farmaco, valutare la comparsa di possibili effetti collaterali e, a fronte di una mancata risposta, rivalutare la diagnosi iniziale.
Per il resto, i tempi del follow up vengono stabiliti caso per caso in base all’evoluzione dei segni clinici e delle alterazioni clinico-patologiche. A tal proposito, la ripetizione serialle delle artrocentesi non è particolaremente raccomandabile nella pratica clinica, in quanto troppo invasiva come procedura di controllo; è preferibile ripetere gli esami emato-biochimici includendo sempre la proteina C-reattiva, ottimo marker di attività inflammatoria della patologia. Il miglioramento clinico restà ad agli il nostro obiettivo primario!
La prognosi è generalmente Buona; nella maggior parte dei casi (90%) la risposta alla terapia sterioidea o combinata è rapida e spesso il trattamento non deve essere continuato a vita.
Esiste purtroppoancheuna percentuale minore di casi più complessi,che non rispondono alle terapie o recidivano frequently,continuando a manifestare
dolore cronico e nei quali si ha una progressiva degenerazione articolare. Inoltre, non è insolito che l’uso prolongato di corticosteroidi o altri immunosoppressori di seconda linea, causi effetti collaterali, ed è quindi importante provare a scalarne il dosaggio e conoscere le diverse opzioni terapeutiche.
Si ricorda infine che le forme erosive, fortunatamente più rare, sono più difficili da trattareessoando caratterizzate ormai da alterazioni anatomiche e funzionali permanenti e progressive dei tessuti articolari.
Francesco Dondi, Università di Bologna e Esperto MYLAV in medicina interna. Walter Bertazzolo, EBVS European Specialist in Veterinary Clinical Pathology (Dipl. ECVCP); Diretlore Scientifico di MYLAV.
Che informazioni possono derivare dallo valutazione dell’escrezione delle proteine urinarie nei gatti nefropatici? Uno studio recentamente pubblicato sul Journal of Feline Medicine and Surgery ha indagato质疑 aspetti in due gruppi di gatti nefropatici e di controllo. Ve ne riassumiamo i risultati e le conclusioni in quello post.
In quello post di aggiornamento bibliografico vi parleremo di un recente studio pubblicato sul Journal of Feline Medicine and Surgery (Giraldi M, Paltrinieri S, Scarpa P. Electrophoretic patterns of proteinuria in feline spontaneous chronic kidney disease. 22(2):114-121; 2020).
Lo studio ha come oggetto d’indagine l’analisi qualitativa della proteinuria nel gatto nefropatico cronico, eseguitaattraverso I’elettroforesi su agar gel previo trattamento delle proteine urinarie con sodio dodecil solfato (SDS-AGE - sodium dodecyl-sulphate agar gel electrophoresis).
Allo stato attuale, sono poche le evidenze scientifiche descritte in letteratura riguardo i pattern elettroforeti urinari nel gatto nefropatico e, di riflesso, riguardo l’utilità di但这a metodica nell’approccio diagnostico al paziente nefropatico felino. Gli autori dello studio si sono quindi posti l’obiettivo di descrivere i pattern elettroforeti urinari sia dei pazienti nefropatici sia dei soggetti a rischio di sviluppare la nefropatia cronica; inoltre è stata indagata la possibile associazione tra specifiche bande eletttoforetiche e la nefropatia cronica.
Per questi scopi sono stati inclusi 70 campioni di urina raccolti da 22 gatti nefropatici a diversi stadi IRIS (44 campioni) e 17 gatti (26 campioni) a rischio di sviluppare nefropatia (ovvero gatti di età superiori a 8 anni o apparrienti a razze predisiste a nefropatia cronica).
I surnatanti dei campioni urinari sono stati quindi saggiati con la metodica SDS-A-GE ed i tracciatiosi ottenuti sono stati valutati per la presenza, tipo di bande elettroforetiche e per il tipo di pattern (Figura 1).
Un primo risultatointerestinge è stato il risconto di bande glomerulari (proteine con peso molecolare maggiore dell’albumina) nella maggior parte dei soggetti clinicamente sani e non proteinurici classificati come a rischio: 22 su 26 (84.6%) esami presentavano bande glomerulari (un esempio nella Figura 1, gatti 2 e 4)

Gli autori ipotizzavano che tali proteine potessero verosimilmente essere rappresentate da cauxina e uromodulina (due proteine fisiologicamente presenti nelle urine di gatto),或者其他 che da ridotte quantità di albumina. Questo risultato sottolinea che l’esame qualitativo della proteinuria, eseguito senza tenere conta del rapporto PU/CU e di una valutazione clinica del paziente, più essere molto utile se non fuorviante.
Un ulteriore importate risultato è stata l’associazione statisticamente significativa tra bande tubulari, ovvero con peso molecolare inferiore all’albumina (Figura 1, gatti 3 e 4), con la presenza di una nefropatia a tutti gli stadi IRIS: 18 su 44 campioni da gatti nefropatici presentavano bande tubulari a fronte di 1 caso nel gruppo dei 26 campioni da gatti a rischio.
Inoltre, 11 su 25 campioni da gatti con PU/CU
presentavano bande tubulari a fronte di 8 su 45 campioni da gatti con PU/CU
, dimostrando una associazione significativa tra proteinuria clinicamente significativa e bande tubulari. La presenza di proteine ad alto peso molecolare non era”Invece associata n’a nefropatia ne a proteinuria quantitativamente significativa. Ciò ha permesso di conclusere che nei pazienti inclusi nella studio, ma probabilitmenteanche nella maggior parte dei pazienti nefropatici sul Campo, la proteinuria è di tipo tubulare, coerentemente con la natura prevalente tubulo-interstiziale del danno renale.
Infine, l’associazione tra bande tubulari e PU/CU
più essere di particolare interesse diagnostico, poiché ci suggerisce che evidenziate un pattern tubulare o misto in pazienti nefropatici con proteinuria borderline (PU/CU compreso tra 0.2 e 0.4) più supportare la diagnosi di proteinuria di origine renale.
Le attuali linee guida IRIS infatti suggeriscono di monitorare i pazienti con proteinuria borderline e di instaurare un trattamento per la proteinuria con PU/CU stabilmente
(dopo aver escludo le altre cause extrarenali di proteinuria).
Sono perché sempre maggiori le evidenze scientifiche, inclua nella negliore. che supportano l’ipotesi che sono iniziati con proteinuria borderline debbano essere considerati patologici e che quindi debbano subire specifico trattamento.
Può essere utile pertanto eseguire l’esame SDS-AGE proprio in questi pazienti nefropatici con costante proteinuria borderline.
Marco Giraldi, Med. Vet., PhD, Staff di MYLAV
Walter Bertazzolo, Med. Vet. EBVS European Specialist in Veterinary Clinical Pathology (Dipl. ECVCP); Direttore Scientifico di MYLAV.
Si tratta di un rilievo clinico ed ecografico molto comune in medicina felina: l’augimento di volume dei linfonodi viscerali intra-addominali. Viene regolarmente, e giustamente, approfondito in primo luogoattraverso una citologia per FNA.
I clinici ripongono molte aspettative in questa procedura diagnostica, ma nell’e sperienza del citopatologo, queste aspettative spesso vengono deluse. Un recente studio ha avvalorato esta ridotta affidabilità della citologia in queste situazioni: cerchiamo di spiegarvi il perché.
Quante volte nella nostra pratica viene riscontato un aumento di volume dei linfonodi viscerali addominali (es. mesenterici, ileo-colici, gastrici, pancreatico duodenali, iliaci mediali, ecc.) nel gatto? Si tratta spesso di pazienti felini con le più disparate presentazioni cliniche: anoressia, ittero, sintomi gastroenterici, dolore addominale, versamento cavitario, e casi via.
Talvolta quosti linfonodi megalici sono associati ad altre anomalie dei visceri, identificabili all’esame ecografico. Giustamente, il primo step diagnostico che viene proposto al proprietario è proprio una citologia per FNA dei linfonodi megalici, nella speranza di poter individuire dei quadri citopatologici specifici di una particolare malattia e di poter escludere soprattutto una neoplasia (es. un linfoma).
Nell’esperienza del citopatologo medio (a cui io apparendo), purtroppo nella maggiordi parte dei casi si rilevano aspetti microscopici poco specifici (es. una infadenopatia reattiva); se siamo più fortunati riusciamo ad individuire quadri più rari e un po’ più indicativi (come una linfadenite piogranulomatosa in un sospetto di FIP, oppure un linfoma dei linfociti granulari o ad alto grado, o addirittura infezioni rare come le micobatteriosi o la criptococcosi).
La situazione più classica è la segunte: gatto con sintomi gastroenterici vaghi e con alterazioni ecografiche della parete gastrica e/o intestinale e con linfoadenomegalia viscerale regionale. Siccome la parete del tubo gastroenterico è difficil-
mente (e spesso con scarsi risultati, a meno che non siano presenti evidenti masse) campionabile mediante FNA, il clinico opta per il campionamento citologico dei soli linfonodi. Ebbene in questi casi è molto difficile raggiungere una diagnosi certa, perché il quadro linfonodale spesso è aspecifico e non è detto che sia correlibale con la patologia primaria.
Un recente studio pubblicato sul Journal of Feline Medicine and Surgery (Correa & Demetriou “Retrospective assessment of the clinical relevance of surgical biopsies of abdominal lymph nodes in cats: 51 cases (2014-2018) ha confrontato i risultati della biopsia istologica linfonodale con quelli dell’esame citologico per FNA, in pazienti felini con vari tipi di patologie (inflammatori e neoplastiche). Sebbene la specificità della citologia per una diagnosi di neoplasia fosse elevata
, la sua sensibilità è risultata inaccettabolmente Bassa (solo il
nel rilevare meta-stasi regionali linfonodali di neoplasie intestinali).

Figura 1 - linfadenite eosinofilica mesenterica in un gatto. Questo rilievo citologico può purtroppo associari s diverse eziologie quali forme inflammatore eosinofiliche/allergiche intestinali, sindrome iper-eosinofilica e soprattutto linfoma T intestinale. Solo una biopsia linfonodale e degli altri visceri permette una diagnosi definitiva.
I motivi di但这a sensibilitàosi bassa possono essere molteplici: il linfonodo campionato piùimplify micro-metastasi all’esame istologico non rilevabili mediente FNA (limite dovuto al campionamento per FNA che più non essere rappresentativo di tutto il linfonodo). Inoltre, multi linfomi alimentari felini sono a basso grado e a piccole/medie cellule: nella valutazione istologica dell’architettura linfonodale, è quasi impossibile identificare queste neoplasia con un FNA del linfonodo interessato.
Questo studio sottolinea quando l’importanza di ottenere campioni istologici multipli (visceri interessati e linfonodi regionali) nei pazienti felini con linfadenomegalia addominale, e di non basarsi sulla sola citologia per indirizzare il problema verso una patologia inflammatoria VS neoplastica, ma di integrare tutti i dati clinici, citoLOGici ed istologici con eventuali altri indagini avanzate (es. immuno-istochimica e PARR) nei casi dubbi.
Walter Bertazzolo, Med. Vet. EBVS European Specialist in Veterinary Clinical Pathology (Dipl. ECVCP); Direttore Scientifico di MYLAV.
Gli Enterococchi sono comuni batteri del tratto gastroenterico e possono causare infezioni del tratto urinario. Queste infezioni sono tuttavia spesso secondarie ad urolitiasi e a problemi anatomici o neoplasie delle vie urinarie. Un recente studio ha studiato nei dettagli le infezioni urinarie da Enterococchi: ve ne riassumiamo i risultati.
I batteri apparomenti al genere Enterococcus fanno parte della normale flora del fatto gastroenterico dei mammiferi. In genere hanno bassa virulenza ma ampia possibilità di crescita in diversi distretti (bile, urine, sangue), il che li rende comunique potenzialmente patogeni.
In medicina veterinaria, Enterococcus spp. nel cane è dal quarto al quinto (in base ai diversi studi) genere di batterio più frequentlymente isolato in caso di batteriuria. Di tutti i cani con batteriuria da Enterococcus spp., circa la metà molto effettivement segni di UTI (“urinary tract infection”).
Uno studio recentamente pubblicato (Wood et al. Risk factors for enterococcal bacteriuria in dogs: a retrospective study. J Vet Intern Med. 2020) has valutato i diversi fattori di rischio che nel cane predispon-gono alle infezioni del tratto urinario sostinente da Enterococcus spp.
Sono stati selezionati due gruppi di cani (lo studio è stato eseguito presso “University of Wisconsin-Madison Veterinary Teaching Ho
Figura 1 - Colonie di Enterococcus spp. in coltura.
spital Microbiology Service”): il primo gruppo è rappresentato da 70 cani con infezione da Enterococcus spp. nelle vie urinarie e 70 cani, utilizzati come controlo, aventi infezione da Escherichia coli nelle vie urinarie. I gruppi sono stati scelti in modo da uniformare età e peso dell’animale.
Dallo studio retrospettivo si è evinto che il fattore di rischio più frequentlyamente associato a batteriuria da Enterococcus spp. è la presenza di anomalie anatomiche del tratto urinario, in minor misura invece risultata essere associata alle urolitiasi e alle neoplasie del tratto urinario. Le urine con batteriuria da Enterococcus spp. inoltré risultano essere maggiorniente concentrate e molto associate alla presenza di piuria, se confrontate con quale positive per Escherichia coli.
Enterococcus faecalis è la spece più frequentlyamente isolata (61%), seguita da E. faecium.
Nonostante quello studio non differenzi la batteriaria asintomatica dall’infezione del tratto urinario vera e proprioia, la combinazione tra potenziale patogeno e tendenza allo sviluppo dell’antibiotico resistenza, cui create un problema a lungo termine. La gestione ottimale di una batteriaria da Enterococcus spp., è pertantoolta a identificare e correggere, se possibile, quale che sono le anomalie predisponenti sottostanti la colonizzazione batterica del tratto urinario.
Marta Medardo, Med. Vet. Responsabile del servizio di Microbiologia di MYLAV.
Walter Bertazzolo, Med. Vet. EBVS European Specialist in Veterinary Clinical Pathology (Dipl. ECVCP); Direttore Scientifico di MYLAV.
Con quello nuovo blog, iniziamo a proporvi una serie di aggiornamenti settimanali su alcune malattie infettive feline molto conosciute, sottostimate e spesso per nulla considerate da loro veterinari. Iniziiamo col parlarvi della leptospirosi, che regolarmente associamo al cane o ad altri animali da reddito, ma che non consideriamo importante per il gatto.

I batteri del genere Leptospira sono numerousi ed includono sua specie patogene che non patogene. Diverse siero-varianti di Leptospira possono causare malattie nell’homme e negli animali. In particolare la leptospirosi umana è una importante e frequente zoonosi. Conosciamo relativamente bene la patologia nel cane e le sue possibili presentazioni cliniche. Ma casa sappiamo del gatto? I gatti sono infet
tarsi? E possono ammalarsi ed essere un rischio zoonotico per l’uomo? Una recente review pubblicata sul Journal of Feline Medicine and Surgery (Murillo et al, JFMS 22: 216-228; 2020) ha approfondito quello argumento molto conosciuto tra i veterinari.
Tutti i mammiferi sono infettarsi con le leptospire. Le diverse specie animali sono fungere da “reservoir” per specifiche siero-varianti (ad es. il cane per L. canicola, il topo per L. icterohaemorrhagiae): quosti serbatoi naturali fungono anche da disseminatori del batterio nell’ambiente e quindi potenziali fonti di contagio per gli altri animali. L’infezione avviene infatti quasi sempre mediante il contatto di cute e mucose con materiale infetto (spesso acqua contaminata ed urina). Questi serbatoi e diffusori sono solitamente animali che si infettano da giovani e che sviluppano una patologia sub-clinica, nelle quelli che si ammalano seriamente sono spesso infetti con siero-varianti a cui non si sono adattati.
I gatti si possono infettare con diverse siero varianti (in particolare Pomona, Grippotyphosa, Australis, Canicola, ecc.). La siero-prevalenza nella popolazione felina varia dal 4 al
in diversi studi condotti in aree geografiche differenti del mondo. La principale fonte di infezione per i gatti, è il consumo di prede infette o di materiale infetto di allevamenti (es. bovini e suini).
I gatti possono quindi a loro volta diventare reservoir dell’infezione e divertare un potenziale rischio per l’uomo e gli altri animali, in quanto divertano eliminatori di batteri con le urine.
La patogenesi è probabilitmente sovrapponibile a quella di altre specie: dopo l’ingresso le leptospire determinano prima batteriemia nella fase acuta (circa 1 settimana post-infezione) per poi distribuirsi in vari organi. Nei tubuli renali sono persistere per settimane o mesi, causando una escrezione urinaria persistente. Sebbene i dati nel gatto siano molto scarsi, le principali azioni patogene delle leptospire sono riconducibili ad un danno renale, con possibile sviluppo di insufficienta renale acuta o cronica, e lesioni epatiche necrotiche ed inflammatore.
I segni clinici possono essere molto variabili, poco specifici e potenzialmente attribuibili a molte altre patologie: sono descritti PU/PD, segni gastroenterici, versamenti cavitari, uveite, dolori diffusi, zoppie eanche lesioni cutanee.
Quanti di moi sospetterebbero la leptospirosi in gatti con quosti sintomi e segni clinici?
Il fatto che non diagnostichiamo mai la leptospirosi nel gatto, dipende principali-mente dal fatto che non la cerchiamo mai, visto che la consideriamo una patologia tipicamente del cane nelle siamo sempre stati propensi a pensare che i gatti siano naturalmente resistenti all’infezione. Anche da un punto di vista delle alterazioni di lavoratorioio, i rilievi possono essere scarsi, poco specifici e perlopiù riferibili ad alterazioni infammatorie acute o croniche e ad una patologia renale, con lo sviluppo di azotemia, riduzione del PS urinario e glicosuria.
Per la conferma diagnostica, valgono le stesse procedure utilizzate per il cane: ricordiamo infatti che le leptospire non possono essere visualizzabili nelle urine con la microscopia del sedimento. è necessario pertanto ricorrere all’identificazione mediante PCR su sangue (in fase acuta) e nelle urine stesse.
Ricordiamoanche che il risultato è fortemente influenzato da eventuali trattamenti antibiotici più iniziati, in quanto questi tendono a far scomparire rapidamente i batteri nel sangue e nelle urine. La sierologia mediante MAT, eseguita nei centri di riferimento per la leptospirosi, è un altro modo valido come per il cane. Si ritiene tutte che le sieropositività nei gatti siano più basse rispetto al cane, ma nei gatti c’è il vantageg di non avee il fattore confondente degli anticorpi di derivazione vaccinale.
Il trattamento dell’infezione è simile a quanto viene descripto per la controparte canina, con fluido terapia di sostegno ed antibiotico-terapia (ampicillina prima e tetracicline successivamente, per ridurre il rischio di escrezione urinaria cronica) quali cardini necessari nelle fasi acute della patologia.
Alcuni pazienti possono tuttavia evolverde ad una patologia renale cronica. A tale proposito non è chiaro il possibile ruolo ed incidenza di questa infezione dello sviluppo delle comuni nefriti interstiziali croniche del gatto, sebbene uno studio abbia dimostrato una magiore prevalenza di sieropositività nei gatti con malattia renale cronica rispetto al gruppo di controllo (Rodriguez et al 2014; JVIM 28: 284-293).
Si ricorda che tale patologia è una zoonosi: le urine degli animali infetti (asintomatici e non) sono una fonte di infezione per gli altri animali e le persone, per cui in caso di positività alla PCR, è necessario adottare misure preventive per evitare il contatto con le escrezioni.
Questo rischio è formente sottovalutato: un recentissimo studio condotto in sud America (Dorsch et al, 2020; PLoS One 15(10): 1-17) su un gruppo di gatti con accesso all’esterno, ha infatti molto una elevata percentuale di soggetti (circa
) con escrezione urinaria di leptospire (PCR e/o coltura positive).
Tutte queste recenti informazioni dovrebbero farci riflettere e iniziare a considerare但这a infezione potenzialmente rilevanteanche per il gatto.
Walter Bertazzolo, Med. Vet. EBVS European Specialist in Veterinary Clinical Pathology (Dipl. ECVCP); Direttore Scientifico di MYLAV.
L’NGAL è un promettente biomarker di danno renale acuto nel cane. Vediamo a casa serve e dove possiamo dosarlo.
La diagnosi di insufficientenza renale acuta o meglio di danno renale acuto (AKI) è basata su diversi rilievi clinici e di lavoratorio:
La diagnosi precoce di AKI più non essere casi semplice: nelle fasi precoci l’augimento di azotemia e creatinina più essere solo modesto o assente. Inoltre non avendo a disposizione i valori basali normali di creatinina del paziente, non è sempre agevole rilevare delle minime variazioni dal suo livello fisiologico.
Un valore di creatinina di 1,6 mg/dL potrebbe apparire molto significativo in un cane che non sta molto bene: ma se lo stesso paziente avesse avuto il giorno precedente un valore basale fisiologico di 1,0 mg/dL, quello improvisivo incremento potrebbe essere più indicativo di danno renale e nascondere presumibilmente un rapido decremento della velocità di filtrazione glomerulare (VFG).
Tale condizione potrebbe essere responsiva al trattamento con fluido-terapia (“Volume responsive Akute Kidney Injury; VR-AKI”; cosiddette forme pre-renali), oppure essere realmente legata ad un danno renale a carico dei nefroni (“Intrinsic AKI; I-AKI”; cosiddetto danno renale intrinseo).
Da decenni si studiano potenziali marker plasmatici ed urinari in grado di individuare precocamente (ovvero prima che augmentino creatinina e urea) il danno renale acuto: l’utilizzo di tali biomarker facilititerebbe il riconoscimento precoce di un AKI e quando promuoveribile una terapia più aggressiva e mirata, fin delle prime fasi della malattia.
Uno dei biomarker più promettenti, utilizzato da quale anno in medicina umana e recentamente investigatoanche in medicina veterinaria è l’NGAL (“Neutrophil gelatinase-associated lipocalin”),una molecola di
prodotta da neutrofilie e cellule epiteliali e coinvolta nella protezione naturale contro le infezioni batteriche

Figura 1 - Necrosi tubulare renale in un esame istologico di cane. (Per gentile concessione del Prof. Luca Aresu, Università di Torino).
(ha il ruolo di impedire l’utilizzo del ferro da parte dei batteri, limitandone la loro crescita e la potenziale diffusione nei siti di infezione).
L’NGAL prodotto nei vari tessuti viene eliminato per via renale, ma vieneanche riassorbito dalle cellule epiteliali dei tubuli renali: un danno a carico di queste cellule cui puziertanto augmentare l’escrezione urinaria della molecola. Le cellule epiteliali tubulari renali producono, inoltre, grandi quantità di NGAL, soprattutto durante un evento dannioso a carico dei nefroni (di natura ischemia, tossica o inflammatoria). L’effetto finale è un aumento dell’escrezione urinaria di NGAL in queste situazioni patologiche: quello aumento repentino più precedere l’instaurarsi delle altre classiche alterazioni riconducibili alla classica insufficientenza renale acuta.
Recenti studi hanno dimostrato come in corso di AKI, sua nelle forme di VR-AKI che in quale di I-AKI, l’escrezione urinaria di NGAL sua molto augmentata rispetto ai soggetti sani.
Un’altra causa di aumento sono i processi inflammatori sistemici, sia per l’ainenata produzione sistematica di NGAL, che per l’eventuale effetto sull’integrità renale. Non sembra che l’ainenato di NGAL sia correlabile alla prognosi dell’AKI ed al tipo di patogenesi. In uno studio recente, ad esempio, animali con AKI da leptospirosi avevano concentrazioni di NGAL molto elevate, ma non differenti rispetto a quella di cani affetti da AKI con cause differenti.
Ricordiamo infine che a differenza dell’SDMA e della creatinina, che sono corralati con la VFG, l’NGAL è un puro marker di flogosi e di danno anatomico/cellulare a carico dei tessuti renali (in particolare dei tubuli).
L’NGAL è finora stato un biomarker utilizzato più che altri in ambito di ricerca e tossicologico, ma dal 2021 saremo in grado di fornire la determinazione di NGAL urinario (sia come valore assoluto, che come concentrazione normalizzata alla creatinina), misurato mediante Tecnologia ELISA, ai clienti del lavoratorio Mylav che ne volessero sfruttare il suo potenziale diagnóstico promettente.
Francesco Dondi, Università di Bologna, Esperto MYLAV
per Medicina Interna e Nefrologia
Walter Bertazzolo, Med. Vet. EBVS European Specialist in Veterinary Clinical
Pathology (Dipl. ECVCP); Direttore Scientifico di MYLAV
La siero-amiloide A (SAA) è una proteina di fase acuta comunamente utilizzata nel gatto per monitorare gli stati inflammatori. Nel cane,inceve siamo tutti abituati ad utilizzato più comunmente la proteina C-reattiva (CRP).
Ma la SAA può essere utileanche nel cane? E chevantaggi più comprare ris-. spetto alla CRP?
Le proteine di fase acuta (“Acute phase proteins” - APP) sono un gruppo di molecole sintetizzate dal fetato, la cui produzione augenta o diminuisce a seguito di stimoli inflammatori di varia natura: quando in un site di flogosi vengono prodotte citochine inflammatore da parte dei leucociti (in particolare granulociti neutrofili, eosinofili e macrofagi).
Questi mediatori agiscono sugli epatociti, fatto augmentare la sintesi di alcune APP (definite per l’appunto APP POSITIVE, ad es. SAA, CRP, Aptoglobina, Fibrinogeno) e fatto diminuire quella di altre (APP NEGATIVE, ad es. Albumina, Transferrina). Sebbene alcune di questi alterazioni biochimiche non abbiano una chiara spiegazione fisiopatologica, si ritiene che si tatti di un adattamento naturale dell’organismo a potenziali agenti patogeni (es. microrganismi) (Figura 1).

Figura 1 - Esempio schematico della fisologia alla base della produzione delle APP.
Ogni specie animale ha APP principali (ovvero quale che si modificano maggiornente) ed altre minori. Ad esempio nel cane la CRP è una APP maggiore nelle per il gatto lo è la SAA.
Ma torniamo alla domanda iniziale, la SAA può essere dosata ed utilizzataanche nel cane?
La prima risposta è si, cui possere misurata, con unsystema sovrapponibile a quello utilizzato routinariamenteanche nel gatto (immunoturbidimetria).Per quanto riguarda la sua possibile applicazione pratica, gli studi disponibili in letteratura sono molto inferiori alla CRP, ma viene evidenziato come:
La SAA in uno studio (Christensen er al 2014) era superiore alla CRP nel discriminare tra forme inflammatoriie e non.
La SAA aumento di più nelle patologie complicate da sepsi (ad esempio in uno piometra complicata da sepsi rispetto ad una non complicata) (Jetpean et al 2014).
Da gennaio 2021 abbiamo pertanto deciso diMETTERA disposizione ed a listino quello biomarker inflammatorioi anche nel cane. Per chi volesse approfondire l’argomento, vi invitiamo allalettura degli studi sotto indicati.
Christensen et al (2013) Canine serum amyloid A (SAA) measured by automated latex agglutination turbidimetry is useful for routine sensitive and specific detection of systemic inflammation in a general clinical setting. J Vet Med Scie 75(4):459-66. doi: 10.1292/jvms.12-0404.
Jetpean et al (2014) Increased concentrations of Serum amyloid A in dogs with sepsis caused by pyometra. BMC Vet Res 28;10:273. doi: 10.1186/s12917-014-0273-9.
Christensen et al (2014) Comparison of serum amyloid A and C-reactive protein as diagnostic markers of systemic inflammation in dogs. Canadian Vet J 55(2): 161-168.
Walter Bertazzolo, Med. Vet. EBVS European Specialist in Veterinary Clinical Pathology (Dipl. ECVCP); Direttore Scientifico di MYLAV.
Alcune epatopatie canine sono caratterizzate da un accumulo patologico di rame negli epatociti: ci sono quindi degli step diagnostici fondamentali da eseguire per poterle diagnosticare correttamente. Ecco quali sono e come poterlo fare.
Il rame è un obligo-elemento esseniziale (co-fattore per molti enzimi) ed il fegato svolge un ruolo fondamentale nel mantenimento della sua omeostasi. Un suo accumulo patologico si può verificare per un difetto metabolico primario, oppure secondariamente ad una alterata funzionalità epatica, con segmente colestasi e alterata escrezione biliare, oppure per un excesso dietetico.
Il rame in excesso a livello cellulare induce uno stress ossidativo, conseunte degenerazione, morte cellulare ed infiammazione. Ne consuegu quindi una epatite cronica. L’epatite cronica primaria è una condizione patologica centrata sugli spazi portali ed è caratterizzata da una flogosi info-plasmacellulare o variabilmente neutrofilica e macrofagica, con occasionale infiltrazione del parenchima periportale (epatite da interfaccia), associata a necrosi/apoptosi epatocitaria, proliferazione duttulare e fibrosi (Figura 1). Numerose razze sono predispose a tossicosi da rame tra le quali si annoverano: Bedlington Terrier, Doberman Pinschers, Labrador, Dalmata, Cocker Spaniel Ingelse ed Americano, Springer Spaniel Ingelse, West Highland White Terrier, Scottish Terrier, Cairn Terrier, Alano, Samoiedo, Yorkshire Terrier e Jack Russell Terrier.
Secondo le linee guida ACVIM, la concentrazione di rame deve necessariamente essere valutata in tutti i casi di epatite cronica primaria. Fanno eccezione i casi di epatite cronica reattiva non specifica, in cui la causa dell’inflammazione non è una condizione epatica primaria, ma è consequencese a stimolazioni inflammatoriie sistemiche (citochine alla circolazione splancnica), in cui il fetato viene coinvolto secondariamente. L’epatite reattiva non specifica è caratterizzata istologicamente da infiammazione lieve o moderata, ma sono assenti la necrosi/apoptosi epatocellulare, fibrosi e rimodellamento architetturale.
Dato che potrebbe essere molto importante individuire una tendenza all’accumulo di rame negli epatociti, come possiamo confermarlo? Abbiamo due possibilità,trambe necessarie e coadiuvanti.

Figura 1 - Epatite cronica da interfaccia con marcata flogosi linfoplasmacellulare e neutrofilica, necrosi/apoptosi epatocellulare, fibrosi a ponte e proliferazione duttale (Ematossilina ed eosina).
Il primo step avviene mediante la colorazione istochimica Rodanina, eseguibile su campioni di tessuto epatico fissati in formalina. La Rodanina, per affinità tintoriale, permette di stimare grossolanamente la quantità di rame all’interno degli epatociti (Figura 2); ci fornisce inoltre informazioni sulla sua distribuzione “spaziale”, ovvero la sua localizzazione nel lobulo epatico. Nei disordini genetici primari (come nel caso del Bedlington Terrier che ha una deficiencies genetica della proteina COMMD1), la localizzazione è primariamente centro-lobulare, con estensione nelle altre porzioni del lobulo man mano che la malattia progredisce. Per contro, un pattern peri-portale è associato ad un accumulo secondario, da colestasi o accumulo dietetico.

Figura 2 - Colorazione istochimica Rodanina: accumulo patologico di rame score 4. Presenti ampi gruppi di epatociti peri-portali positivi con colorazione granulare citoplasmatica grosso-arancio intenso.
Lo “scoring” dell’accumulo di rame avviene mediante un sistema di valutazione visiva che lo classifica in maniera “semi-quantitativa”, assegnando un punteggio che va da 0 a 5, in base alla sua estensione e distribuzione nel lobulo. Un punteggio superiore a 2 viene considerato patologico.
Il secondo step nella diagnosi: il dosaggio quantitativo del rame nel tessuto epatico.
La colorazione istochimica, sebbene garantisce un primo screening iniziale e fornisca informazioni sulla patogenesi della malattia (primaria o secondaria), deve essere accompagnata da un dosaggio quantitativo dell’elemento, mediante spettrofotometria ad assorbimento atomico, che è possibile richiedere nel 2021 nel nostro lavoratorio.
I campioni da mandare per quello tipo di esame devo essere essere biopsie fresche e sono necessari circa 20-40 mg di fetato, equivalenti ad 1 biopsia di 2 cm con 14 G o metà di un campione laparoscopico da 5 mm. Facendo più prelievi bioptici sare possibile richiedere sua valutazione istologica e istochimica (pezzi da fissare in
formalina), che il dosaggio del rame (il frammente bioptico dovrà essere mantenu-to refrigerato/congelato fino all’invio al laboratorioio).
La quantificazione del rame è il tipo più accurato ed è considerato il “gold standard” secondo l’ACVIM.
Nel cane, si considerino le seguenti linee guida (adattate da Cullen & Stalker 2016; Strickland et al 2018; Webster et al 2019); si tengàconto tuttavia che esiste una notevole variabilità di razza e che negli ultimi decenni si è assistito ad un incremento delle concentrazioni di rame epatico, probabilmente a causa di cambiamenti ambientali e/o dietetici.
Cullen and Stalker. Liver and Biliary System. In: Jubb, Kennedy, and Palmer’s Pathology of Domestic Animals, 6th Edit., Vol. 2, MG Maxie, Ed., Elsevier, St. Louis, 2016.
Hoffmann G. Copper-associated liver diseases. Vet Clin North Am Small Anim Pract. 2009 May;39(3):489-511.
Webster et al. ACVIM consensus statement on the diagnosis and treatment of chronic hepatitis in dogs. J Vet Intern Med. 2019 May;33(3):1173-1200.
Strickland JM et al: J Vet Intern Med. 2018;32:1943-1950
Luisa Vera Muscatello, Med. Vet., EBVS European Specialist in Veterinary Pathology (Dipl. ECVP), Università di Bologna e team dei patologi di MYLAV. Walter Bertazzolo, Med. Vet. EBVS European Specialist in Veterinary Clinical Pathology (Dipl. ECVCP); Direttore Scientifico di MYLAV.
La Proventricular dilatation disease (PDD) definita recentemente Avian Ganglioneuritis (AG), è una patologia comune in molte specie di pappagalli e di altri uccelli.
È stata riscontrata per la prima volta nei pappagalli “ara” negli anni settanta del secolo scorso. Gli animali colpiti risultano positivi al Bornavirus aviare, che determina un deperimento progressivo e causa la morte del pappagallo.

La sintomatologia clinica si manifesta solo in pochi soggetti; la maggior parte degli animali positivi resta infatti asintomatica.
La AG è stata documentata in pappagalli e uccelli di altre specie, sia selvatici che allevati in cattività, tra cui tucani, canarini, verdoni, oche canadesi e falchi pellegrini. Sono interessate più di ottanta specie di pappagalli, principamente di taglia grande come cenerini, ara, amazzoni e cacatua. Tuttavia, il virus è stato isolatoanche in pappagalli più piccoli quali parrocchetti monaci e inseparabili.
Le principali manifestazioni cliniche sono anoressia, emaciazione, presenza di materiale indigerito nelle feci, dilatazione del gozzo e diminuzione del “body condition score” (BCS). Gli animali colpiti presentano atrofia dei muscoli pettorali e alla visita clinica è possibile valutare il tipico aspetto del petto “a lama di coltello”.
L’infezione causa dilatazione del proventricolo, distensione duodenale e ridotto transito dell’alimento. In rari casi è stata descritta la presenza di miocardite con lesionsi a livello del cuore destro con morte improvvisa anche in pazienti apparentemente sani (Rossi et al. 2018).
Sono disponibili diversi test, ma la metodica più attendibile sembra essere la ricerca degli anticorpi anti-gangliosidi, da effettuare nei pazienti che manifestano sintomi neurologici e/o gastroenterici.
L’iter diagnostico potrebbe essere completato alla biopsia del gozzo, che risultata essere diagnostica nel
dei pazienti (Berhane et al. 2001; Kistler et al. 2010), e nella ricerca virale mediante PCR effettuata da tampone cloacale.
L’eliminazione del virus tuttavia è intermittente e la ricerca con PCR potrebbe non individuare la presenza (Heffelsat al. 2012; Piepenbring et al. 2012). L’iter diagno
stico deve essere completato da un esame emato-biochimico completo e dallo studio radiografico della cavity celomatica per evidenziar la dilatazione del proventricolo. Nei Lori la dilatazione del proventricolo, ventricolo e duodeno è spesso assente (Doneley et al. 2007).
Il test si esegue su quantità minime di siero o plasma di Psittaciformi; il quantitativo minimo richiesto è di 50 microlitri.
Dal 2021 saremo in grado di fornire quello test tra gli esami dedicati alle specie aviarie.
Berhane Y, Smith D, Newman S, et al. Peripheral neuritis in psittacine birds with proventricular dilatation disease. Avian Pathol 2001; 30:563-70. 33.
Doneley RJ, Miller RI, Fanning TE. Proventricular dilatation disease: an emerging exotic disease of parrots in Australia. Aust Vet J 2007; 85:119-23.
Kistler AL, Gancz A, Clubb S, et al. Recovery of divergent avian bornaviruses from cases of proventricular dilatation disease: identification of a candidate etiologic agent. Virol J 2008; 5:88.
Heffels-Redmann U, Enderlein D, Herzog S, et al. Follow-up investigations on different courses of natural avian bornavirus infections in Psittacines. Avian Dis 2012; 56:153-9.
Piepenbring AK, Enderlein D, Herzog S, et al. Pathogenesis of avian bornavirus in experimentally infected cockatiels. Emerg Infect Dis 2012; 18:234-41.
Rossi G., Dahlhausen R., Galosi L., Orosz S.E., Avian Ganglioneuritis in Clinical Practice. Vet Clin Exotic Anim 2018; 21 Elsevier Inc.
ArdizzzoneF.:https://allevamentodottssaardizzzone.com/pdd-proventricolite-dilatativa-nei-pappagalli-indagini-diagnostiche-associate-e-gestione-della-patologia/
Gustavo Picci, Esperto MYLAV per gli animali non convenzionali.
In quello secondo capitolo sulle patologie infettive/infestive negrete del gatto, parliamo delle filariosi, intendendo sia le infestazioni cardiopolmonari causate da Dirofilaria immitis che nelle sottocutanee causate da Dirofilaria (Noctiella) repens. Prendiamo spunto da una recente review pubblicata sul Journal of Feline Medicine and Surgery (Pennisi et al., JFMS (2020) 22: 442-451), per darvi alcuni input su queste patologie ampiamente diffuse ancne nel nostro territorio nazionale.
Le caratteristiche eziopatogenetiche e parassitologiche della filariosi cardiopol-monare felina non differiscono da quella canina. Tuttavia nelle cane rappresenta l’ospite di elezione e sviluppa comunamente microfilariemia, necessaria per la trasmissione della parassitosi con i vettori, i gatti invece rappresentano un ospite accidentale/imperfetto e di solito non hanno microfilariemia rilevante.
Solo una piccola percentuale di L3 inoculate dai vettori sono infatti raggiunge rile stadio adulto, in tempo pressché doppio rispetto a quello nel cane (7-9 mesi contro i 4-6 mesi); inoltre le dimensioni dei parassiti adulti nel gatto sono inferiori e raramente si riproducono, in quanto dificilmente si possono avere infestazioni con un numero di maschi e femmine sufficienti. I vermi adulti nel gatto infine vivono meno a lungo rispetto a quelli che parassitano i cani.
La diffusione delle filariosi feline è sovrapponibile a quella canina, essendo legata al medesimo tipo di trasmissione. Tuttavia, sebbene la forma cardiopolmonare nel cane si via ridotta in termini di incidenza, grazie alle sempre più diffuse attività profilattiche, si è invece assistito ad una subdola diffusione della meno seriala forma sottocutanea causata da N. repens.
L’augimento globale delle temperature e l’istaurarsi di inverni sempre più miti, hanno inoltre favorito la diffusione dei vettori (zanzare dei generi Aedes e Culex in particolare),anche in paesi prima poco interessati dal problema (es. il Regno Unito ed i paesi del Nord Europa).A causa della dificilità di ottenere una confirma diagnostica definitiva (vedi altri), è impossibile stabilire l’entities reale della diffusione di queste parasitosi nei felini domestici.
La patogenesi delle lesioni arteriose e polmonari indotte dalla filariosi cardiopol-monare felina è simili a quella del cane; le lesioni possono essere secondarie alla infestazione cronica, maanche alla morte dei parassiti adulti, con rilascio di fram-menti di parassita e di batteri endo-simbionti (Wolbachia spp.), in grado di scatenare tromboembolismo polmonare, violente reazioni inflammatore polmonari e sistemiche, talora fatali. La maggior parte dei gatti tuttavia va incontrato a infesta-zioni asintomatiche o con segni clinici alquanto specifici (es. sintomi respiratori cronici, vomito ed anoressia).

Figura 1 - Alcune filaire adulte all’interno delle camere cardiache di un gatto.
Le forme sottocutanee di filariosi sono diagnosticate raramente, in quanto quasi sempre asintomatiche: solitamente i parassiti vengono identificati all’interno di le sioni nodulari dopo FNA o accidentamente durante chirurgia ed esami istologici.
Per i vari aspetti sopra descriotti la diagnosi è dificile: rilevare micro filarie è alquanto raro, perché i classici test antigenici utilizzati nel cane, hanno nel gatto una Bassa sensibilità a causa del ridotto numero di parassiti adulti. Più sensibili sono invece i test indiretti, che permettono l’identificazione di pazienti sieropositivi, che hannocioò sviluppati anticorpi contro gli antigeni parassitari. Per le medesime ragioni (pau-ciparassitismo)anche l’ecocardiografia,utilizzata per rilevare parassiti adulti nelle camere cardiache, non è dotata di elevata sensibilità (Vedi schema in Figura 3).

Figura 2 - Microfilaria accidentally rilevata durante un esame citologico in un gatto.
Non ci sono trattamenti adulticidi approvati e standardizzati come per il cane,anche perché la maggior parte dei gatti si libera dell’infestazione in pochi mesi/anni. Trattamenti cortisonici e terapia intensiva sono,inveceindicati e necessari in casodi pazienti con sintomi respiratori severi, shock e tromboembolismo.Nelle area a rischio, sono,inveceindicati i trattamenti chemio profilattici per prevenir lo svi
lutto di parassiti adulti, a base di ivermectina, mibelmicina ossima, moxidectina, selamectina ed eprinomectina (principi attivi e relativi prodotti commerciali diversi per nazioni).

Figura 3 - Schema consigliato da Pennisi et al (JFMS 2020) per l’approccio diagnostico alla filariosi polmonare del gatto.
Luigi Venco, Med. Vet. EBVS European Veterinary Parasitology Specialist
(Dipl. EVPC); Esperto MYLAV.
Walter Bertazzolo, Med. Vet. EBVS European Specialist in Veterinary Clinical
Pathology (Dipl. ECVCP); Direttore Scientifico di MYLAV.
8 OCCHIO ALLA RAZZA!
12 VARIABILITA ANALITICA E BIOLOGICA: PRENDIAMO ESEMPIO DALLA CONCENTRAZIONE URINARIA
15 LA VALUTAZIONE DELLA CONCENTRAZIONE DELLE URINE: PS E OSMOLALITA
18 COLORAZIONI ISTOCHIMICHE ED IMMUNOISTOCHIMICHE
26 CHE SUCEDE A QUESTO BIOCHIMICO? - ERRORI DA EVITARE
27 IL TIPO DI PRELIEVO DI URINE INFLUISCE SU PROTEINURIA E CORTISOLURIA?
29 DI FILARIOSI CARDIOPOLMONARE NEL CANE
33OPS-L’ACTH MI E USCITO FUORI VENA…CHE FACCIO CON IL MIO TEST DI STIMOLAZIONE?
35 L’ASPIRAZIONE DELLE LESIONI SURRENALICHE É RISCHIOSA?
38 PARR: ISTRUZIONI E AGGIORNAMENTI PER UN CORRETTOUTILIZZO
44 COMPREPARE I PEZZI CHIRURGICI PER LA VALUTAZIONE DEI MARGINI DI ESCISSIONE
52 COME EFFETTUARE UN CORRETTO CAMPIONAMENTO PER L’ESAME TRICOSCOPICO E LE SUE FINALITA
56 IL MASTOCITOMA DERMICO DEL CANE: COSA É NECCESSARIO FARE
64 IL MASTOCITOMA SOTTOCUTANEO DEL CANE: COSA POSSIAMO FARE?
68 LE MALATTIE TRASMESSE DA VETTORI IN ITALIA: DIFFUSIONE E PREVALENZA
73 ERRORI DA EVITARE: COME NON STRISCIARE UN CAMPIONE DI MIDOLLO OSSEO
76 COME VALUTARE LA SALUTE DEL CANE IN BASE ALLA SUE ETÀ: LE LIFE STAGE GUIDELINES
82 COME VALUTARE LA SALUTE DEL GATTO IN BASE ALLA SUE ETÀ: LE LIFE STAGE GUIDELINES
87 ERRORI DA EVITARE: FARE ESAMI DI APPROFONDIMENTO PRIMA DI QUELLI DI BASE
90 IL RUOLO DEI VIRUS NELL’ONCOGENESI DEI TUMORI DEL CANE
92 NODULI SPLENICI DEL CANE: QUANTI SONO REALMENTE NEOPLASTICI E MALIGNI?
97 RETROVIROSI FELINE (FIVE FELV): LE NUOVE LINEE GUIDA 2020 DELL’AMERICAN ASSOCIATION OF FELINE PRACTITIONERS (AAFP)
104 ERRORI DA EVITARE: IL GEL ECOGRAFICO, AMICO DEL RADIOLOGO, NEMICO DEL CITOLOGO
107 PERCHÉ É IMPORTANTE L’ISTOLOGICO LINFONODALE DELL’ITER DIAGNOSTICO DI UN SOSPETTO LINFOMA?
111 LA POLIARTRITE IMMUNO-MEDIATA: COME FACCIO A FARE LA DIAGNOSI?
118 LA POLIARTRITE IMMUNO-MEDIATA COME FACCIO A TRATTARLA E MONITORARLA?
123 ALCUNE NOVITA’ SU SDS-AGE NEL GATTO NEFROPATICO
126 LINFONODI INTRA-ADDOMINALI MEGALICI NEL GATT: LA COTOLOGIA SPESSO NON BASTA
129 IMPORTANZA DELLA BATTERIURIA DA ENTEROCOCCUS SPP. NEL CANE
131 LE MALATTIE INFETTIVE NEGLETTE DEL GATTO: LA LEPTOSPIROSI
135 UN NUovo MARKER DI DANNO RENALE: LA MISURAZIONE DEL NGAL NELLE URINE
138 LA SAA NEL CANE
140 COME E QUANDO DOSARE IL RAME NEL FEGATO?
144 A COSA SERVE LA MISURAZIONE DEGLI ANTICORPI ANTI-GANGLIOSIDI NEGLI UCCELLI?
147 LE MALATTIE INFETTIVE NEGLETTE DEL GATTO: LA FILARIOSI

MYLAV
Laboratorio La Vallonea
Il laboratorio dei clinici per i clinici

MYLAV s.r.l.u.
SEDE LEGALE: Via Vecchia Montesardo, 21
73031 Alessano (LE)
SEDE DEL LABORATORIO: Via G. Sirtori, 9
20017 Passirana di Rho (MI) - Tel: +39 02 931 1172
info@laboratoriolavallonea.it
www.laboratoriolavallonea.net
www.mylav.net